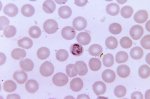

Что на третьем пике?
Ваши действия?
Всж, дядь
Мы все черви под ногами начмеда!
Нейросети помешают психиатрию или нет? А то чет очково.
Как нейросети будут привязывать пациентов, лечить делирий и шизофрению с изоляцией олигофренов, идиотов и дементных бабок?
Тренажёр тестов для аккредитации
Только что приехал с конфы, где была секция про нейросети в психиатрии. В реальности пока только в НИИ Сербского сделали подобие системы помощи принятия клинических решений при постановке диагноза, точность на уровне восьмидесяти процентов. Пока это все доползет до практической психиатрии пройдет еще много лет. И само собой разработчики сидеть не собираются, так что дохтур зицпредсепателем будет подписывать все нейропокаки еще оче долго
>много лет
Ну много это сколько? Пять десять тридцать?
Ты все равно крайний будешь, расслабься
Интересно, как перекатошиз-русофоб на ОЗИЗ ходить будет, у него ж там пердачело разорвётся буквально.
Зачем ему ходить куда то
Короче 5й курс, хочу начать ходить в кружок по нейрохирургии. Есть смысл? Сразу поясню, что хочу перекатиться в Мальту, так что рад советам
Что думаете по поводу Крита? Хочу открыть свою частную практику в микенском дворце.
Хуею с этих ХОЧУ СХОДИТЬ НА КРУЖОК.
Кружки созданы чтобы на них ходить, это не ординатуру выбирать, пиздуй раз хочешь
Есть кто с академа возвращался? Если у меня, например, в семестре до академа предмет был не закрыт, но я его посещал, могу ли я закрыть пропущенные занятия и закрыть его в нынешнем семестре?
Что думаете про ординатуру ОЗЗ
Говорят хороший ворклайф баланс
Хорошие зарплаты в дс
Не работаешь с пациентами
Бумажная работа около юридическая
Хорошие зарплаты в дс
Не работаешь с пациентами
Бумажная работа около юридическая
Про перекат в Мальту что скажешь? Сильно трудно?
?
Спрашиваю же
> Что думаете про ординатуру ОЗЗ
> Говорят хороший ворклайф баланс
> Хорошие зарплаты в дс
> Не работаешь с пациентами
> Бумажная работа около юридическая
Все похуй на каком ты читаешь. На каком хочешь. Тут никто на серьёзе не учится, ты явно тредом ошибся, если думал, что тут тебе будут единомышленники с которыми ты будешь обсуждать американские учебники и перекат. Как видишь - нет. Это я даже без негатива говорю.
А по факту: для себя читай на английском. Для того чтобы сдать экзамены - то что дают на учебе. За твои вумные мысли из пабмеда какой-нибудь старый маразматик тебя только завалит.
Ты сначала определись, на Мальту ты или в Германию. Английский универсален, но лучше дрочить все в будущих формулировках экзамена страны переката. Даже между пиндостаном и бриташкой пиздец какая разница местами
>определись
Определился, в Германию. Поэтому вопрос и возник: очевидно, если ты к USMLE готовишься, то даже смотреть на р. материалы смысла нет.
>формулировках экзамена страны переката
Ну конкретно к FSP я буду сильно позже готовится, плюс фундаментальные дисциплины я не вижу смысла разбирать на немецком, да и пока я его плохо знаю, а скоро уже патология, фарма етц. Клиническое уже точно буду на немецком читать.
>единомышленники
Так они тут есть, я поэтому и сижу тут до сих пор. Самого разговорчивого анона я, конечно, на пораше выловил, но итт тоже много инфы наваливали.
>для себя читай на английском
Почему?
Что про перекат на Фарерские острова известно?
я оттуда, спрашивай
Язык сразу фарерский учить? Как диплом РФ подтверждать?
Есть смысл подаваться в Филиппины? Или слишком сложно и невыгодно?
В чём шутка? В треде уже давно пришли к выводу, что нужно ехать либо в Америку, либо в Германию.
Королевство Тонга это хидден гем, рекомендую.
Хидден гемс - это Финляндия и может быть Швеция.
Морозопидерахия, скандинавовымираты и прочие Сюрстрёмминговые паханаты не интересуют. А вот насчет переката в Парагвай хотелось бы подробнее.
Морозопидерахия, скандинавовымираты и прочие Сюрстрёмминговые паханаты не интересуют. А вот насчет переката в Парагвай хотелось бы подробнее.
Глянул тгшную группу одной столичной ПКБ. Там стандартный такой контент вот мы с шизами зарядку делаем, вот главврач наш такой прекрасный, на лацкане значок понятной партии, вот наш коллектив. Епты, а почему врачи выглядят как пациенты, только в халатиках и с позолоченым бейджем, такие отечные, волосы сальные, взгляд безжизненный. Ну и ремонты писец, в палласовке црб богаче ремонтом из вент панелей. А тут столичная пкб
Соматиков посмотришь такие улыбаются, в евроремонтах, скалятся белыми зубами на фоне новенького лор комбайна или щелевой. Причем в том же районе.
Соматиков посмотришь такие улыбаются, в евроремонтах, скалятся белыми зубами на фоне новенького лор комбайна или щелевой. Причем в том же районе.
Ты бы еще инфекционку глянул
Гайс, напомните ресурсы, где можно статейки всякие почитать научные. Можно и на англюсике в том числе. Кроме е-лайбрери нихера не помню.
любые медики в РФ это второй сорт людей: низкие зарплаты, соответствующее дерьмовое отношение, проблемы с головой, змеинный коллектив,
не пизди на инфекционистов
Кто нибудь обращался к медюристам? были прецеденты?
Медач
Каналы в тг
Если прям научные то кохрейн и пабмед
В этой стране все такие, даже бандиты-чиновники. Проклятая земля.
В палласовке нормально башляют, не мороси. Врачи статные, поджарые, челюсти мощные от обилия мяса в рационе, есть бицуха и пресс потому что есть время в качалку ходить, а не пукать 40 минут на от в одну сторону, дух спокойный у них , поезда умиротворяют и не надо иноземский язык учить и кучу тестов решать
Насколько трудно иммигрировать в Уругвай? По сравнению с РФ сильно лучше?
Бохатые ребята. На ставку фельдшера аж 24 тыщи рублей в месяц, на ставку лора 33 тыщи у них в разделе "вакансии"
А ты две ставки возьми + путинские + бонусы + праздничные дни + выплаты молодому
Район отличается сложившейся и достаточно развитой инфраструктурой.
В шаговой доступности от больницы находятся: остановка общественного транспорта, остановка такси, аптека, сеть магазинов «Магнит», «Пятерочка», «Покупочка», торговый центр, кафе, парикмахерские, банкомат Сбербанка, Россельхозбанка, ВТБ-24, авто и железнодорожный вокзалы. Для сотрудников, имеющих детей дошкольного и школьного возраста рядом находятся три детских сада, две больших школы. По окончании школы, у детей есть возможность продолжить обучение в Палласовском сельскохозяйстенном техникуме, который также находиться недалеко от больницы. Все объекты доступны для всех категорий инвалидности.
В шаговой доступности от больницы находятся: остановка общественного транспорта, остановка такси, аптека, сеть магазинов «Магнит», «Пятерочка», «Покупочка», торговый центр, кафе, парикмахерские, банкомат Сбербанка, Россельхозбанка, ВТБ-24, авто и железнодорожный вокзалы. Для сотрудников, имеющих детей дошкольного и школьного возраста рядом находятся три детских сада, две больших школы. По окончании школы, у детей есть возможность продолжить обучение в Палласовском сельскохозяйстенном техникуме, который также находиться недалеко от больницы. Все объекты доступны для всех категорий инвалидности.
Уже бегу все три брать. Мне ж поебать на себя, лет до 30 поживу и можно смело отъезжать прям на рабочем месте от какого нить окс или онмк
⚡️Медицинские учреждения обяжут за свой счёт покупать аудио-оборудование для контроля за врачами
Напомним, ранее губернатор Вологодской области Георгий Филимонов анонсировал начало борьбы с хамством медработников: «Мы говорим об искоренении неэтичного отношения к пациентам и хамского общения со стороны сотрудников медучреждений».
Теперь опубликован проект приказа минздрава области — все медорганизации области должны будут закупить аудиобейджи за собственный счет. Ориентировочная стоимость аудиобейджей, согласно открытым данным, 6 тыс— 30 тыс. руб.
Аудиоконтроль общения сотрудников регистратуры, а также приемов участковых терапевтов, педиатров, ВОПов, фельдшеров (в случае возложения на них функций врачей), стоматологов, зубных врачей будет проводиться со 2 июня.
Медики получат речевые инструкции, а в конце рабочего дня записи проанализируют — если обнаружат некорректные с точки зрения инструкции фразы, «провинившегося» доктора вызовут на разборки к главврачу.
Документ также обязует назначить ответственных «за ежедневную оценку и анализ аудиозаписей».
Че пацаны кто в проверяльщиков правильности общения собирается вместо галер?
Напомним, ранее губернатор Вологодской области Георгий Филимонов анонсировал начало борьбы с хамством медработников: «Мы говорим об искоренении неэтичного отношения к пациентам и хамского общения со стороны сотрудников медучреждений».
Теперь опубликован проект приказа минздрава области — все медорганизации области должны будут закупить аудиобейджи за собственный счет. Ориентировочная стоимость аудиобейджей, согласно открытым данным, 6 тыс— 30 тыс. руб.
Аудиоконтроль общения сотрудников регистратуры, а также приемов участковых терапевтов, педиатров, ВОПов, фельдшеров (в случае возложения на них функций врачей), стоматологов, зубных врачей будет проводиться со 2 июня.
Медики получат речевые инструкции, а в конце рабочего дня записи проанализируют — если обнаружат некорректные с точки зрения инструкции фразы, «провинившегося» доктора вызовут на разборки к главврачу.
Документ также обязует назначить ответственных «за ежедневную оценку и анализ аудиозаписей».
Че пацаны кто в проверяльщиков правильности общения собирается вместо галер?
> Че пацаны кто в проверяльщиков правильности общения собирается вместо галер?
Как таких называть будут интересно
Ебать коновалов, ебать! Чтобы как андроиды на алгоритмах работали за калории для поддержания жизнедеятельности и койко-место с комнатной температурой. Лишнее слово сказал не по сценарию - утилизация бракованного с последующей заменой на уважаемого приглашенного иностранного специалиста.
по цито!
Что плохого в иностранных специалистах
Из гермашки все съебывают в СШП и швейцарию, на их место едут говорящие на местном хуже таджиков выходцы из восточной эуропы и Великой России, а тут тоже надо работать, насратулло еще не худший вариант, он хоть немного в детстве русский учил по учебникам о колонизации великого Турана мерзкими русскими, мог бы приехать тумбаюмба или еще какой камбоджиец
Мне жаль медсестер, рутинная работа без перспектив, какое же дно, в районе курьерства. Я даже не уверен что вытяну 18 месяцев этого. Но сука надо работать хотя бы на хлеб на 0.5.
И чёт задумался какое же ахуенное УЗИ, надо выбрать спецу с возможностью переподготовки по нему, чтобы взять где-нибудь 0.25 ставки и отдыхать подрабатывая. Опять же АиГ походу.
И чёт задумался какое же ахуенное УЗИ, надо выбрать спецу с возможностью переподготовки по нему, чтобы взять где-нибудь 0.25 ставки и отдыхать подрабатывая. Опять же АиГ походу.
Аир может на узи переподготовиться. Но кому нужен узкопрофильный узи специалист?
Узи это дополнение к основной специальности
В полке/стационаре/часке часто есть кабинет узи, где челикс до обеда узирует по заявкам и съебывает в другое место делать узи за прайс побольше. Не пыльно, спокойно, околонулевая ответственность. Найти себе место вполне реально, мб даже дежурства какие-нибудь.
К таким мыслям невольно обращаешься со временем, когда уже перегорел основной работой или нечто выбивает тебя из колеи. Вот бы на узиста/лаборанта/рентгенолога/другаянепыльнаяспецаname отучиться... Эхх, ладно. Бля, в приемник зовут. Ладно, потом помечтаю.
>А вот у барина...
Кек.
>Что плохого?
Ну смари дарагой.
@
Либо ты мне 20к и я делаю тебе в плановом порядке лапароскопию завтра, а мой дарагой друг доктор Мамут Рахал сделает тебе прекрасный легкий наркозик.
@
Либо мая хурять твоя лапаротомия наживую наскока хватать бюджетного наркоза.
@
Своим скидка.
МНЯНИЕ?
Выпускников медвузов обяжут отрабатывать 3 года в больницах или поликлиниках. Соответствующий законопроект разработал Минздрав РФ. Он касается всех, кто обучался на бюджетной основе. В случае отказа отработать положенный срок выпускнику грозит штраф в размере тройной стоимости обучения — в среднем около 3,6 млн рублей. Эта мера направлена на решение проблемы нехватки медицинских кадров в стране
Это же в сеченовке до 1кк доходит за год? 6кк за 6 лет. 18кк штраф?
Мимо хочу в этом году поступать, постоянно думаю что я дурачек, т.к. на бюджет не пройду. Получается, это даже к лучшему?
Мимо хочу либо перекат сразу, либо на орду психиатрии. Вот уже по специальности я бы 3 года отработал
Выпускников медвузов обяжут отрабатывать 3 года в больницах или поликлиниках. Соответствующий законопроект разработал Минздрав РФ. Он касается всех, кто обучался на бюджетной основе. В случае отказа отработать положенный срок выпускнику грозит штраф в размере тройной стоимости обучения — в среднем около 3,6 млн рублей. Эта мера направлена на решение проблемы нехватки медицинских кадров в стране
Это же в сеченовке до 1кк доходит за год? 6кк за 6 лет. 18кк штраф?
Мимо хочу в этом году поступать, постоянно думаю что я дурачек, т.к. на бюджет не пройду. Получается, это даже к лучшему?
Мимо хочу либо перекат сразу, либо на орду психиатрии. Вот уже по специальности я бы 3 года отработал
>либо на орду психиатрии
тебе бы лечь прокапаться в психиатрию, на хуя ты в медицину прешь? Тут дно, беги
Не будет, твёрдо и чётко. Когда я поступал 2 года назад, точно так же прогревали.
Насмешил
Одна жалоба и этот иностранный специалист увольняется к хуям / депортируется или садится. Так как знакомых кроме таких же маструбеков, даст бог если врачей, у него нет.
А у нашего местного Ерохина дядя в росздравнадзоре, кент в следственном комитете, а мама главврач и на твои жалобы ему глубоко похуй. Да еще и возьмет с тебя не 20к, а все 200
Минздрав предложил втрое повысить штраф для выпускников медвузов, отказавшихся от обязательной трёхлетней работы в больницах и поликлиниках
Речь идёт о тех, кто учился за счёт бюджета. Теперь неисполнение условий может обойтись примерно в 3,6 млн рублей.
В ведомстве считают, что такая мера поможет сократить дефицит врачей в государственных медучреждениях.
Речь идёт о тех, кто учился за счёт бюджета. Теперь неисполнение условий может обойтись примерно в 3,6 млн рублей.
В ведомстве считают, что такая мера поможет сократить дефицит врачей в государственных медучреждениях.
Не примут. А если примут, то примут так, что ничего платить не надо будет. ВСЖ.
Даже если прям жёстко введут, то банальное: поступил на бюджет, отучился 11 семестров на бюджете, на 12 перевёлся на платку, выпустился как платник, пыня сосёт хуй.
И попиздовал работать в госку все равно. Умом.
Перекат в Гватемалу. Реально?
Нихуя не будет.
Перекат в Попабаву, к Мицголу. Реален?
Я не буду работать на этой стране.
Есть смысл ехать в столицу и отваливать 1кк за орду? Лор специальность, насколько вообще марка орды влияет?
Там просто не дадут тебе ничего делать. Это раз. По завершению орды не возьмут работать. Это два.
Поступать в орду есть смысл только в дс. Это три.
Почему? Парадокс
Если поступишь в орду за мкадом, то выпустишься врачом. Если поступишь в орду в столице, то возможно во время учебы среды возможностей найдешь способ не быть врачом
>Если поступишь в орду в столице, то возможно во время учебы среды возможностей найдешь способ не быть врачом
А кем
Это поди общаться надо, коммуницировать. Фу фу фу
Ну да можно просто по течению плыть
>По завершению орды не возьмут работать.
Это еще почему, в Москве вакансий много
Да суетиться западло
Я долбоёб.
В тредах вообще были настоящие перекатившиеся? Или одни первокуры-селюки, грезящие дойчландами и швятыми?
Ни одного
https://pastebin.com/LaPxG6WK
из оп поста
из оп поста
Один анон в Финляндии, два в Германии.
Не пизди.
Без пруфов
Кидали геолоки и розетки. Но пруфы так себе, тут соглы.
>Кидали геолоки и розетки
Пруф уровня /b. Пусть мб хотя бы визами пруфанут.
>Oh, just noticed that you’re looking to practice medicine here—landing work as a foreign physician in CH can be an annoying process, per a German doctor friend of mine. Although Switzerland needs more doctors, there’s a protectionist system in place that favors graduates of Swiss medical schools—foreign licenses don’t necessarily transfer automatically, and many of the most lucrative private-sector medical jobs are not open to foreigners until they’ve completed a period of poorly-paid, laborious service (essentially an additional residency) in a Swiss public hospital. My German doctor friend had to turn down a cushy job offer from an urgent care/walk-in clinic because she hadn’t completed this service, and now works across the border in a German clinic of some kind.
>In some cases for some job openings, EU doctors may be able to access exemptions, but it’s not guaranteed, and my friend was unable to accept a private-sector job offer without a supplemental residency. German doctors actually face a few unique restrictions, officially because there are differences between the Swiss and German pharmacopeia, and Swiss and German medical labs use different measurements for a lot of tests—mg/DL vs mmol/L, others.
>I have also been told that many Swiss patients don’t want to see foreign doctors, but urban Switzerland is very international, so it’s not a big barrier to working in a city. But I doubt an immigrant doctor would thrive as a rural GP.
>In some cases for some job openings, EU doctors may be able to access exemptions, but it’s not guaranteed, and my friend was unable to accept a private-sector job offer without a supplemental residency. German doctors actually face a few unique restrictions, officially because there are differences between the Swiss and German pharmacopeia, and Swiss and German medical labs use different measurements for a lot of tests—mg/DL vs mmol/L, others.
>I have also been told that many Swiss patients don’t want to see foreign doctors, but urban Switzerland is very international, so it’s not a big barrier to working in a city. But I doubt an immigrant doctor would thrive as a rural GP.
Надо ввести заперт на выезд молодых специалистов. Если хотят выехать - пусть выплачивают сумму, за которую их обучили.
А я на платке
Ты то на платке, то на бюджете. Определись уже, Мироненко
Мироненко это германия/швейцария шиз. А я в сша хочу
>швейцария
Больше нет, см.
Сначала поеду либо в Померанию, либо в Саксонию, а там посмотрим: либо останусь в ФРГ, либо поеду в США.
Пошел нахуй
сшашиз
Новые правила читай. Пока ты будешь по 80 часов в неделю ебашить даже без гринкарты (если тебя вообще возьмут), я буду кайфовать в Дрездене с немецким паспортом. Встретимся в Алабаме, малютка.
Вот это охуенный чел. Соль земли
Чет он прекратил тут ныть про унижение он старшухи, вообще все местные болезные пропали, и инцелы, и вадичка. Тред теперь микробложик илюшки мироненко, его покаки трут регулярно, но он упрямый серунишка же
Полный тред фантазеров. Кому, лол, нужен совковый врач в Европе?
Это кстати подлеченный Владислав.
Даже у него есть тян
Что у больной?
иерсиниоз
Обоснуй.
Не он
рок герой!
Брюшной тиф.
Босния и Герцоговина. Что по перекату?
Да
Народ, подскажите. Это правда, что терапевт в поликлинике получает нынче 70-80к? Звучит очень хорошо, но почему спрашиваю - есть ли смысл переезжать в Андорру? Или уровень жизни по итогу просядет?
Тред "анон шыз разговаривает сам с собой"
давай следующую задачку
Меня напрягает что часто легко поставить диагноз в задачах, но на этом они не останавливаются. А спрашивают не диагноз, а что-то такое. Я блядь постоянно в состоянии "да я что помню это, я глазами пробежал и не вчитывался когда это у нас было"
Вот это реши
А хотя понятно почему я не понял как это решить.
Ладно все. Не буду превращать это в бложик
Ладно все. Не буду превращать это в бложик
откуда тесты?
Эти на amboss.
Где подвох? B.
Вот тут хз, гуглить не стал. Вообще без понятия что из перечисленных продуктов гемолиз вызвать может.
Спасибо, Илья, а то ты заебал, честно, создай себе отдельный блог
Это не я, последний мой пост - это паста про Швейцарию (там потом чел уточнил, что он имел ввиду только частную практику, а в госки попасть очень легко).
Я нихуя не делаю, не хожу на пары, ем доставочки и просто тихонько отбываю срок.
Не слишком ли самонадеяно для перекатуна? Весь мозг жиром заплывет.
Желаю всем коллегам стойкости в этот траурный день бтв.
> В
Подводных нет потому что ты прав. Молодец
А второе это североамериканская тема. У нас такого штамма походу нет. https://ru.wikipedia.org/wiki/Escherichia_coli_O157:H7
Я сейчас 4 курсе, цикл инфекционных болезней заканчивается. Готовлюсь к экзамену и сверху полирую задачками усмлевскими. Чувствую себя удручающе. Я привык заучивать билеты для экзамена, а не учить предмет. Вот тут все проблемы и вылезают.
Трехлетняя девочка была доставлена в отделение неотложной помощи из-за боли в груди, которая длилась 2 часа. Восемь дней назад она была госпитализирована в больницу для лечения от субфебрильной температуры, недомогания и боли в горле. Госпитализация осложнилась фарингитом с образованием псевдомембран и тяжелой шейной лимфаденопатией, потребовавшей кратковременной интубации. В детстве пациентке не делали плановых прививок. Исследования сыворотки крови показали повышенный уровень сердечных тропонинов. ЭКГ показывает диффузную инверсию зубца Т и продолжительный интервал между приемами. Прием чего из перечисленного во время предыдущей госпитализации, скорее всего, предотвратил бы сердечные симптомы у этой пациентки?
Что за диагноз и что выберете в задаче?
Что за диагноз и что выберете в задаче?
Загнивают. А вот у нас её обязательно бы привили. Горжусь Россией.
Свободная страна. Хотят прививают, не хотят не прививают
Вот базовое видео на тему: https://www.youtube.com/watch?v=I_Bb2EdX2_0
Ты посмотрел? Требования к работникам специально завышают на бумаге, чтобы платить меньше. Смысла реально учиться нет. Это реально.
Определенная доля правды в этом наверняка есть, однако не стоит возводить скилл в абсолют. Если ты не можешь отличить макулу от папулы и лечишь через чатгпт то зачем такой работник нужен?
Да, но то, что реально надо знать до орды, можно выучить за два года неспеша.
Я посмотрел. Это хуйня. Чем больше айтишников и меньше вакансий, тем сложнее устроиться на работу и меньше зпшка. Это очевидно. Закон спроса и предложения. Чтобы это понять надо смотреть ролик на ютубе? Хочешь получить вакансию - качаешь навыки, которые нужны бизнесу, делаешь подходящее резюме.
Требования завышают если на рынке дохуя айтишников, которые хотят попасть на твою галеру. За что платить им большие деньги, если есть другой айтишник, который готов взять эту работу за меньшую зпшку? Дефицит кандидатов ушел. Нельзя просто закончить буткемп курсы и долбиться в джуновские вакансии, пока от горящего рынка и дефицита кандидатов тебя возьмут на дообучение.
Так у нас не только рецессия в экономике, когда деньги можно не экономить ха-ха так и большой уровень глобализации после ковида. Если ты не хочешь работать и приносить прибыль, то наймут индуса на удаленку. Ты должен быть производительнее чем десять индусов, чтобы составлять ему конкуренцию.
Это в 60-90ых человек устраивался в компанию, ему оплачивали колледж и он работал на корпорацию пока не выйдет на пенсию и еще пенсию от корпорации будет получать.Это время со всеми его плюсами и минусами ушло. Кстати минусов там было не мало.
Это был социальный контракт по форду и японским дзайбацу. Популярная тема в западной культуре, но ты не поймешь. У нас было ссср, а потом сразу рф с новой кап экономикой.
Новая кап экономика она стоит на фрилансерах и временных работниках, которые работают на многие компании по своей карьере. В этом есть свои плюсы и минусы.
Ждем следующий цикл роста экономики, который позволит кормить кучу людей на bullshit jobs.
А если говорить не про айтишников, а про рабочие профессии типа электриков/инженеров/всякие подобные. То там есть профсоюзы, которые ограничивают вкат в профессию. Чтобы нельзя было пройти трехмесячные курсы и получать зпшку выше среднего. У айтишников таких профсоюзов нет ahahahaha. Сами себе лохи и виноваты.
Так электрик должен наработать стаж, и допуски, чтобы у него повышалась зп/час. И если сначала он ученик и получает немного, то с возрастом доход растет.
И есть ли в этом минусы? Есть. Нельзя просто взять и устроиться на работу с крутой зп. Но зато есть защита от таких вкатунов. Если ты работаешь 15 лет на этой должности, то ты стабильно получаешь зпшку и уверен в завтрашнем дне, и что тебя не уволят ради индуса, который берет чуть меньше. Это Skills Gap.
Поэтому и нужно выбирать такие профессии, которые защищены таким образом с помощью образования. Например врачом стать сложно, большие требования к обучению. Но если их пройти, то будешь получать свои хорошие условия работы.
Если этот Skills Gap стеклянный потолок убрать, то мы вернемся к закону спроса и предложения и получим безработицу как в айти.
Автор что коммунист?? Хочет заставить корпорации нанимать американцев на работу чтобы они там лоботрясничали???....
Шутка. Он просто мажет свои сказки в духе woke культуры для тупых пиндосов, чтобы они ненавидели трампа
Хуйню высрал.
>Например врачом стать сложно, большие требования к обучению. Но если их пройти, то будешь получать свои хорошие условия работы.
А вот эти хорошие условия, они с тобой сейчас водной комнате?
Ой в последнем скрине не видно, но там $550K for full-time work, including retention bonus
В какой штат ты поедешь?
В какой возьмут
Но мне нравится NYState. Хотя конечно я даже еще не был в америке. Только по ночам. Она мне снится.
Кто-то работал на скорой? Как экзамены сдам на инфекцию пойду устраиваться. Я немного волнуюсь. Можете меня успокоить и сказать что там ничего страшного и если что меня подстрахуют? А то вдруг я минингококковую инфекцию не отличу, сыпь не увижу. Страшно!
Кто-то работал на скорой? Как экзамены сдам на инфекцию пойду устраиваться. Я немного волнуюсь. Можете меня успокоить и сказать что там ничего страшного и если что меня подстрахуют? А то вдруг я минингококковую инфекцию не отличу, сыпь не увижу. Страшно!
Крутится малютка...
Смоделируем ситуацию
У тебя в отделении лежит бомж с гангреной обоих ног. Воняет на 2 этажа вниз и вверх. Бомж бесхозный, деть его некуда.
Есть 3 варианта:
1. Ждать когда он откинется от гангрены
2. Сделать ампутацию обоих ног, провести послеоперационное лечение, лично оформить ему группу инвалидности и несколько месяцев пытаться перекинуть его куда-то
3. 50 единиц инсулина + 2х6,0 дексаметазона
Что ты выберешь?
У тебя в отделении лежит бомж с гангреной обоих ног. Воняет на 2 этажа вниз и вверх. Бомж бесхозный, деть его некуда.
Есть 3 варианта:
1. Ждать когда он откинется от гангрены
2. Сделать ампутацию обоих ног, провести послеоперационное лечение, лично оформить ему группу инвалидности и несколько месяцев пытаться перекинуть его куда-то
3. 50 единиц инсулина + 2х6,0 дексаметазона
Что ты выберешь?
Второе.
Он потом на улице мне будет собирать на нового китайца. Будет сидеть в форме и табличкой я ветеран
в чем смысл 3-го действия?
если только инсулин в/в
Ускорить 1-й вариант
Ускорить 1-й вариант
>несколько месяцев пытаться перекинуть его куда-то
Для этого существует начмед и/или заведующий.
Больничка и ты за 2 вариант деньги получают из омс. Вы там для большего нихуя не нужны.
>Гыгы, ща мы его инсулином... А в дозатор физраствор... Я мизантроп.
Просто дурак.
Инсулин убьёт кору, но не сам мозг.
Знаю человека, пытавшийся в суицид инсулином, по итогу год лежал в коме, потом умер от сепсиса из-за пролежней.
В случае острой интоксикации на фоне гангрены, инсулин и декс дают божественный эффект.
А какой дозой? Сам думал про это. И что делать тогда?
>декс
Оно продаётся в аптеке?
мимо
Суицидник мамкин, съеби отсюда.
Что тут?
A
Ждем, когда трампыня снимет санкции и откроет прометрик центр в богоспасаемой.
Да. Эбола
Ладно, с завтрашнего дня начинаю жёстко учить немецкий вместо пар, а то что-то отстаю ото всех.
Че про перекат в Индонезию расскажете?
Переезжаешь в ФРГ, получаешь там специализацию, едешь куда хочешь.
Просто понимаете, благородного человека всегда тянет к благородному - к Италии, к Испании, к Франции, к SPQR и латыни, а не к дерьманцам и дерьмании. Если бы только там денег давали...
А здесь чем лечить будете и какой диагноз?
Бавароублюдия, бюррократовымираты не интересуют вообще
С днем медсестры
Лептоспироз. Безжелтушная форма, лечим доксициклином.
Была бы желтуха цефтриаксон в/в
Да.
А тут что
а почему при безжелтушной доксициклин?
спасибо!
Жить с мыслью, что это твоя единственная жизнь, нравится тебе она или нет.
Легкая форма
А ты медсестричка или медбратик?
Я утром - я вечером.
Сдать экзамен в вузе на 5 сложнее, чем решить тесты усмл на эту тему. Усмл задачки вообще простые если не решать их с ходу, а сначала пройти тему на нужных ресурсах. В вузе сложнее. Я признаю, что это информация, которую неплохо бы знать. Но в учебнике про это один абзац где-то в жопе текста. Я не знал, что это важно. Я это не закреплял. А это есть в задачке для допуска к экзамену.
> При тяжёлом течении гриппа повышение проницаемости сосудов на уровне ЦНС сопровождается гиперсекрецией спиномозговой жидкости с развитием внутричерепной гипертензии (менингизм); возможно развитие отёка мозга. Микроциркуляторные нарушения в гипоталамусе и гипофизе приводят к нейроэндокринным и нейровегетативным нарушениям и усугубляют уже ранее имевшуюся нейроэндокринную патологию. В связи с этим в группу риска тяжёлого течения гриппа входят пациенты с метаболическим синдромом, беременные.
Если об этом помнить, то задачку решить просто. А я не помнил. Ну блядь. Обидно, что я не могу загрузить информацию в мозг как в компьютер.
Еще и заучить лекарства не получается. Ерунда какая-то.
Терапия вич еще с оппортунистическими заболеваниями. Или АРТерапия при вич. Как всю эту плеяду препаратов запомнить?
тенофовир + эмтрицитабин + долутегравир просто набор случайных буков. Не укладываются в голове. Я никогда раньше не учил терапию, только патологию. Точнее я учил, но только класс препарата. Типа а похуй. Я же класс препарата помню. Типа окей там нужно макролиды юзать. А че за макролиды я в душе не ебу ни один не назову. Не представляю как их учить. Так еще там основной препарат, препарат выбора, препарат для детей беременных, препарат при резистентности (по возможности желательно сказать).
А они почему то решили что нужно спрашивать кроме названия лекарства еще и продолжительность и объем терапии. Я названия антибиотиков запомнить не могу. А тут еще дозу надо говорить. Просто жесть.
Почему инфекционные болезни такие сложные? У меня последний раз такой вайб был когда я сдавал гистологию. Со второго по четвертый курс все было на чиле.
Сдать экзамен в вузе на 5 сложнее, чем решить тесты усмл на эту тему. Усмл задачки вообще простые если не решать их с ходу, а сначала пройти тему на нужных ресурсах. В вузе сложнее. Я признаю, что это информация, которую неплохо бы знать. Но в учебнике про это один абзац где-то в жопе текста. Я не знал, что это важно. Я это не закреплял. А это есть в задачке для допуска к экзамену.
> При тяжёлом течении гриппа повышение проницаемости сосудов на уровне ЦНС сопровождается гиперсекрецией спиномозговой жидкости с развитием внутричерепной гипертензии (менингизм); возможно развитие отёка мозга. Микроциркуляторные нарушения в гипоталамусе и гипофизе приводят к нейроэндокринным и нейровегетативным нарушениям и усугубляют уже ранее имевшуюся нейроэндокринную патологию. В связи с этим в группу риска тяжёлого течения гриппа входят пациенты с метаболическим синдромом, беременные.
Если об этом помнить, то задачку решить просто. А я не помнил. Ну блядь. Обидно, что я не могу загрузить информацию в мозг как в компьютер.
Еще и заучить лекарства не получается. Ерунда какая-то.
Терапия вич еще с оппортунистическими заболеваниями. Или АРТерапия при вич. Как всю эту плеяду препаратов запомнить?
тенофовир + эмтрицитабин + долутегравир просто набор случайных буков. Не укладываются в голове. Я никогда раньше не учил терапию, только патологию. Точнее я учил, но только класс препарата. Типа а похуй. Я же класс препарата помню. Типа окей там нужно макролиды юзать. А че за макролиды я в душе не ебу ни один не назову. Не представляю как их учить. Так еще там основной препарат, препарат выбора, препарат для детей беременных, препарат при резистентности (по возможности желательно сказать).
А они почему то решили что нужно спрашивать кроме названия лекарства еще и продолжительность и объем терапии. Я названия антибиотиков запомнить не могу. А тут еще дозу надо говорить. Просто жесть.
Почему инфекционные болезни такие сложные? У меня последний раз такой вайб был когда я сдавал гистологию. Со второго по четвертый курс все было на чиле.
про какие тесты говоришь? какие примеры билетов/вопросов в ВУЗе?
АРВТ разве есть в общем курсе инфектологии?
> про какие тесты говоришь?
USMLE
> АРВТ разве есть в общем курсе инфектологии
Ну у меня есть вич и его терапия. А где оно должно быть?
> какие примеры билетов/вопросов в ВУЗе?
Ну я тебе не скопирую, но вот как помню в тексте. Пациент с: острое начало, лихорадка 40 градусов, инъекция склер, гиперемия лица, цианоз губ, белый налет на языке, миндалины чистые, боль в мышцах, боль в глазах, усиливающаяся при движении головы, петихии на задней стенке глотки, сыпи на теле нет. Сухой кашель, однократное носовое кровотечение, в легких сухие хрипы. Тон сердца глухой. Симптом пастернацкого нет, печень и селезенка не увеличены. Диурез и стул в норме. Ригидность затылочных мышц, но симптом кернига и брудзинского нету. Чувство саднения за грудиной. У пациента несколько раз была рвота, постоянная тошнота. Пациент тучный, с сахарным диабетом.
ЧСС 120 АД 100/60 Дыхание 24 тахипноэ.
И еще куча другой информации, которая не является клинически значимой и не может использоваться для дифференцировка, но призвана заставить студента утонуть в тексте и не найти важные симптомы и синдромы.
Какие синдромы?
Какой диагноз?
Какие обследования?
Какое лечение?
И тут я сел в лужу. Тут вам блядь и налет на языке, который должен смутить студента. Тут и ригидность, которая меня смутила больше всего, ведь я не знал про минингизм при гриппе. Тут петихии, которые могут смутить студента подумать на инфекционные болезни, с пятнами во рту. Это конечно другое, но если плохо помнить, то ведь смутишься. И боль в груди + отдышка + цианоз, но хрипы сухие и это вроде не пневмония, но пневмония частое осложнение гриппа. И думашь че тут грипп с осложнениями, или менингококк какой-то смешанный ведь есть ригидность, и сейчас начальная стадия и пока сыпи на теле еще нет. А и нахуй они написали про боль в мышцах? Это намек на лептоспироз? Да не я лептоспироз хорошо помню там такого точно нет, да и нет поражения почек печени. А может это вообще ковид? Какая-то дыхательная недостаточность. Боли в груди (вирусный миокардит?). Да бля.... Кароч надо вывозить базар и хорошо знать. А в усмл че. Ну вот тебе 5 признаков малярии, узнал? А теперь скажи это p. ovale или p. falciparum? Молодец, идем дальше.
Как лечить будем тяжелый грипп с менингизмом? Тред будущих врачей медиков, ваши ответы?
Как лечить будем тяжелый грипп с менингизмом?
Жду мнения всех анонов итт
Жду мнения всех анонов итт
не буду я не инфекционист
закрывайте тред
А кто ты
>Со второго по четвертый курс все было на чиле.
но мне же говорили, что с 4го курса полный рассос и ничего не надо делать??? емм двач???
Маленький троллинг :)
оооо неееет то есть мне придется реально учиться все шесть лет????
Нет. Только за неделю перед сдачей экзаменов
это начиная с 4го курса?
С первого
Треды скатились в детский сад, ясли и шизу 2 ебланов. Ливаю. Раньше хоть было смешно и между "хи-хи" вставки от молодых врачей разных спецух.
>Делай вставки сам
>Кто?! Я?!
>Кто?! Я?!
я решил отложить немецкий и попытаться закрыть долги
я на иммунологию вообще ни разу не ходил, хз будет ли препод выебываться
Какую еще иммунологию ты на втором курсе
Расскажите плиз про вступительные после колледжа, на лечебку в медвуз. Там как ЕГЭ, или темы, более связанные с медициной? Например, в био, в 2-3р больше заданий с анатомией, генетикой?
А с русским и химией как? Все как в ЕГЭ?
А с русским и химией как? Все как в ЕГЭ?
ну у нас на втором иммунология зачетом. а где то не так что ли?
Так и есть. Какие вопросы вообще?
Ты спроси прямо у преподов к этому причастных, если вы +- неплохо общаетесь. Слышал, там дичайший рассос и дают списывать. Не миллионник.
Бляяяяяяядь. Почему он, а не я?!
ну там чел сказал что с четвертого курса ему стало сложнее
всем салам. хотел бы спросить: перевод в другой вуз. как это все делаете? каковы шансы что переведут, а если переведут то на бюджет или коммерция? абсолютно не шарю за это, но перевестись хочется
кто переводился расскажи че как делали все
кто переводился расскажи че как делали все
Пытался из первого меда дс2, в пироговку. Приносишь план учебный своего вуза в деканат между семестрами, они сверяются с программой своего вуза, если все ок переводят, если есть бюджетные места, то на бюджет.
У меня в итоге не сошлась программа по часам, из за физры лол, почему то в пироговке была какая то особенная доп. Физра. Предлагали только с потерей курса, ну они нахуй и пошли.
>но перевестись хочется
нахуя?
>из первого меда дс2, в пироговку
зачем? ладно бы в сеченовку
Хотел в мск переехать(был дурак)
>>1052444
Я буду репортить все твои посты
>Ты спроси прямо у преподов к этому причастных
Где таких найти?
>если вы +- неплохо общаетесь
Ни кого из вуза не знаю..
>Слышал, там дичайший рассос и дают списывать. Не миллионник.
Так же, не миллионник. В подслушано вуз нейм мне написала тян, говорит купила ответы (варианты которые будут на ВИ, и ответы к ним, до самих ВИ) у чела 1 по 10к за предмет. Скинула ссылку. Там на фото дяденька в костюме. Но это фейковая фотка-находится через яндекс. Посмотрел историю профиля-там раньше фотки и имя, какого-то азера были. И в сети редко бывает. Хз похоже на скам
Вполне возможно, что скам и она просто зазывала продаван. Надежней всего будет поискать и спросить таки поступивших по внутренним из вашего техникума. Хоть кого-нибудь. Не думаю, что там будут конченные шакалы, которые удавятся за инфу.
Каких преподов? Хз, мб прямо к руководству типа вашего куратора или декана факультета/курса. "Хелоу драсте, расскажите, как наши внутряки сдают." На первых курсах мб еще будут козлить и в хуй вас не ставить, а на последних как-то проще с ними общаться и тебя уже знают. Все взрослые люди. А люди могут общаться и договариваться.
1й не мой. че в 4м было?
Я не с мед колледжа, с другого..
Если не с медкалича, то какие вообще внутряки могут быть? Либо из него по внутренним, либо после егэ на общих основаниях.
Так с любого колледжа, в любой вуз, можно внутряки сдавать. Ну со след. года пофиксят это, только на похожее направление можно будет. В этом поступать планирую
город другой увидеть хочу или как щас модно говорить "выйти из зоны комфорта", хочется поступить в более мощнее учебное заведение.
+ вечный стереотип, что в моем городе горе врачей обучают, и из-за этого желание перейти большое
Значит меньше ебут, значит можно больше ебланить 6 лет.
не хочу, я потом как лечить то буду((
а там смотрят на оценки? допустим я ебалдуин на 3/4 учусь?
А похуй, меньше ожиданий - меньше заебывать будут.
Умненьким всезнайкой быть невыгодно, зарплата такая же как у ебланов, а требований сверху дохуя.
Если вуз есть в wdoms и имеет аккред, то похуй какой он.
Копиум
уже нет, малютка. теперь в сша принимают только топ тир вузы - чеченский, ингушский, барнаульский. масковские и пидерские не принимают
сука у меня после твоих слов аж внутренняя борьба началась
Быть хуевым специалистом? Хуйня идея. Такие быстро выгорают и меняют профессию на таксиста.
я терапоид терпилоид дебилоид работаю 6 часов без вызовов норм зп + дарят канфеты я их жру в 1 фейс. Мнение?
Выгорание наступает не из-за того что ты тупой, а из-за того что ты не видишь результат своего труда. Делаешь план - план растёт, пиздец не лечится, а хуйня сама пройдёт, в социальной роли ты обслуга об которую вытирают ноги.
В госшарагах лучше всего свои сильные стороны при их наличии не показывать, умных и активных всегда грузят решать вопросики с жалобщиками, кабанчиками и истеричками, заставляют переделывать работу за дебилами, завышают ожидания в рутинных делах. А когда ты будешь увольняться тебя ещё и виноватым выставят, предателем коллектива и гондоном.
А у твоей академии есть?
Я чечен, я ингуш, я барнаулец. Дсблядки сасать.
У моего Первого Среди Равных, Лучшего Медицинского Вуза страны есть.
Какой же ты торпидный. Хотя это конечно естественно для эпилептиков.
WFME аккредитация НЕ НУЖНА для получения ECFMG. Если в Sponsor Notes есть пометка ECFMG, то ты можешь подаваться на матч. Я бы тебе не отвечал, но твою херню читают другие аноны.
Чекать тут https://search.wdoms.org/
Кстати, просто напоминаю, что из германии в сша по немецкому диплому тебя работать не пустят. Ухаха
инб4: сойджак, который мгновенно получит репорт
Я адыгеец
ДС2блядки сосать
>НЕ НУЖНА
а, ну да
>из германии в сша по немецкому диплому тебя работать не пустят
https://www.medsmarter.com/blog/u-s-states-allowing-international-doctors-without-residency/
швейцария лучше энивей, без понятия нахуя ты в пикрил помойку рвешься. ты чурка?
лучше бы я конечно в айти пошел
А мне нравится
в айти можно работать по 4 часа в день из дома и не надо ничего учить и ни с кем разговаривать
еще в айти селедок нет и в целом коммьюнити менее токсичное
фантазер
итт уже очень токсичная атмосфера а тут даже не врачи сидят
в айти такого нет
я врач
погромисты те еще токсики если не успели попить латте на миндальном и лавандовый раф среди рабочего дня
В АйТи писдец тока там в 25 уже эйджат. А если в 30 то косятся.
А в медицине вон девчонка в 39 заканчивает лечку, народ в 30+ и ниче, работа есть слова не скажут
Даже лучше, солиднее выглядят
В АйТи писдец токсично там в 25 уже эйджат. А если в 30 то косятся.
А в медицине вон девчонка в 39 заканчивает лечку, народ в 30+ и ниче, работа есть слова не скажут
Даже лучше, солиднее выглядят
Еще в айте зумеры калового скриптонита слушают и чбд смотрят фу мля это писдец прикиньте
В медицине хоть можно в олдом дежурить и он макс уральским пельменей включит
В медицине хоть можно в олдом дежурить и он макс уральским пельменей включит
Кипелов рулит пиздюки вонючие
Рэп это кал и тик токи
Рэп это кал и тик токи
Скриптонит и чбд уже для скуфеющих зумеров. И вообще зумеры устаревший мем, нынешние школьники и со следующего года уже студенты принадлежат к поколению альфа
Так Москва же, похуй ни них.
Когда прикроют лавочку для пёзд, что они берут целевое, проходят без конкурса, в медшараге залетают/ выходят замуж и могут не отрабатывать в больничке родной мухосрани? Терапевта нету в городе, потому что пёзды абузят систему(мужики терапевтами не работают очевидно). Ну а вообще вас коновалов надо как при совке принудительно отправлять работать в маленькие города лет на 15, если на бюджете отучились. Ну а для коммерции ценник на обучение сделать х10 как в пиндосии.
Терпи. Бюджетную медицину убивают постепенно, ценник за обучение сделают как в пиндосии по твоим требованиям, врачей станет дефицит и тогда все будет как пиндосии - цены на лечение тоже, вот скотинка-то взвоет.
>Когда прикроют лавочку для пёзд, что они берут декрет, на работе или учебе залетают/ выходят замуж и могут не отрабатывать у кабана в родной мухосрани? Рабской силы нету в городе, потому что пёзды абузят систему(мужики сдохли на гойде/спились не работают очевидно). Ну а вообще вас крестьян надо как при совке принудительно отправлять работать в маленькие города лет на 15, если на бюджете отучились. Ну а для коммерции ценник на обучение сделать х10 как в пиндосии.
Поправил тебя, уебак. Ты со всеми в одной лодке.
>Место работы: офисname
Блять, да сделайте вы удаленку.
Бюджетной медицины не существует уже, алло. Рэкетиры в халатах даже перед бюджетной операцией просто медсестричку подсылают и говорят: хотите чтоб операция прошла максимально хорошо и без осложнений, передайте в конвертике денежку (немалую). Хотите нормальную палату, а не со спидозными бомжами, платите. И тд. Такой коррупции и беспредела как в медицине нет ни в одной другой сфере.
Так это коррупция в рамках бюджетной медицины. В частной/страховой будет все тоже самое, но оффициально и с прейскурантом.
Буквально на сайте любой кгбузхуюз или ее странички на сайте минздрава есть кнопка противодействие коррупции. Жмите. Жалобы работают.
просто залети своей бойпиздой
И что тебе не нравится, скуфяра? Врачи тебе ничем не обязаны и им, вот сюрприз, насрать на тебя.
Знаю ситуацию, когда хирург зашел в палату к послеоперационному пациенту, который не захотел оплачивать весь спектр его услуг, и распустил швы на коже.
Че за бред
А терапевтического профиля врачи подсылают и че говорят?
Напишем в выписке так, чтобы не дали инвалидность.
Поступаю в мед. Есть ли там какие-то кружки, секции всякие? Какие?
За спорт можно степуху повышенную получать и пары прогуливать официально? Если да, за какой спорт?
За спорт можно степуху повышенную получать и пары прогуливать официально? Если да, за какой спорт?
бля... зачем это все на хуй?
Сейчас в ВУЗах не требуют знаний, ни навыков, тупо делают из тебя раба. Чтобы ты послушно кивал бабкам сракам в поликлинике, назначал уровень вит Д, ферритин, и хфизио лечение. Тупо имитация для совкового населения.
В моей пол-ке для бабок срак сделали бассейн. Недавно была 120 кг пизда, у торой ГБ ХСН метаболический синдром, пришла с жалобой на суставы( я ЛОР ) просто она мне жаловалась я ей говорю: "не пробовали ЗОЖ и вес снизить" Она начала вопить на меня, сказала что ходит на массаж. Еще один скуф пришел лечить гепатит после того как в частной клинике ему делали пиявки и капельницы курс ( 110 т)
Условия работы:
• График работы сменный
• Полное соблюдение ТК РФ
• Для членов Профсоюза реализованы следующие проекты:
• Медицинское сопровождение;
• Созданы спортивные команды из числа членов ППО и работников принимающих участия в официальных соревнованиях от Департамента здравоохранения Москвы и Московской Федерации Профсоюзов;
• Бесплатные занятия по Йоге;
• Скидочная программа в столовой на территории больницы;
• Поездки на тематические экскурсии, курорты, Здравницы;
• Льготная программа в детских оздоровительных лагерях;
• Скидки и бесплатные билеты в театры, на мюзиклы, спектакли, при условии наличия специального предложения от организаторов;
• Помощь при поступлении ребёнка в первый класс;
• Помощь при принятии ребёнка в детский сад;
• Участие в благотворительных мероприятиях.
• График работы сменный
• Полное соблюдение ТК РФ
• Для членов Профсоюза реализованы следующие проекты:
• Медицинское сопровождение;
• Созданы спортивные команды из числа членов ППО и работников принимающих участия в официальных соревнованиях от Департамента здравоохранения Москвы и Московской Федерации Профсоюзов;
• Бесплатные занятия по Йоге;
• Скидочная программа в столовой на территории больницы;
• Поездки на тематические экскурсии, курорты, Здравницы;
• Льготная программа в детских оздоровительных лагерях;
• Скидки и бесплатные билеты в театры, на мюзиклы, спектакли, при условии наличия специального предложения от организаторов;
• Помощь при поступлении ребёнка в первый класс;
• Помощь при принятии ребёнка в детский сад;
• Участие в благотворительных мероприятиях.
Есть кто стажировался в цивилизованных странах, кто был туристом, у нас старшие курсы в 00-е в Германию по обмену гоняли( я нет )
У них такой же дибилизм там? Куча жалобщиков, ноющие старухи, бумажные проволочки, МСЭ?
Помню старшаки рассказывали как в Гермашки каждому выдают медодежду, как уходя просто скидываешь шмотки в прачку, условия работы, чистоту в туалетах. Вроде даже на консиллиумах сидели, в ординаторской кофе гоняли
У них такой же дибилизм там? Куча жалобщиков, ноющие старухи, бумажные проволочки, МСЭ?
Помню старшаки рассказывали как в Гермашки каждому выдают медодежду, как уходя просто скидываешь шмотки в прачку, условия работы, чистоту в туалетах. Вроде даже на консиллиумах сидели, в ординаторской кофе гоняли
>Помню старшаки рассказывали как в Гермашки каждому выдают медодежду, как уходя просто скидываешь шмотки в прачку, условия работы, чистоту в туалетах. Вроде даже на консиллиумах сидели, в ординаторской кофе гоняли
Старожилы говорят, что в совке примерно также было, кек
Кровавый спорт
Вообще хоть за шахматы
У меня возник вопрос: в связи с ни с кем нескрываемой грядущей ёбли выпускников медвузов во все отверстия: буквально будешь работать там где скажут (просто подадут заявку, что нет кадров в ЦРБ N и устроишься только туда) — кто они, те, кто хочет все еще поступать в медицинский?
Расскажите плез о дополнительных наборах в вузы, в августе. В этом году будет (приняли же закон что уменьшают места)?
Получается, я в августе могу подать документы, если что? Ну и там будут баллы ниже, чем в основной период, на платку?
Получается, я в августе могу подать документы, если что? Ну и там будут баллы ниже, чем в основной период, на платку?
Меня позвали на собес туда
Идти? Записываться в красные козлы?
не будет
Твердо и четко?
А вы говорили медицинский колледж не пригодится. 75к плотют за работу обезьянки.
Какие-то сказочные долбоебы. Или романтики
да
Больше пяти лет назад отчислился из пироговки, могут ли хотя бы в теории восстановить или засчитать часы, если заново поступать?
Нахуя?
Девчуля тут у нас ходит дежурить ночь в общую хирургию уже больше трех лет БЕСПЛАТНО за то что бы поработать как врач дали ну и на проеб видимо!!! спрашиваю скок платят хирургу 40-50к, молодые приемку обслуживают и гнойное, весь план держат олды. И то там не какие то фантастические суммы на карман.В полке хирург под сотку получают. Руками только бородавки срезает.
И в чем прикол стационара?
И в чем прикол стационара?
-ну типо потом можешь выйти в топ и делать какие то лапароскопии хитрые и брать на карман (нет не получится)
- на дежурствах в раковину ссать и ебать медсестер
Больше плюсов нет
Раньше такое практиковали, когда в желаемом стационаре/полке не было вакантных мест (не было по разным причинам, мб кто-то не желал ставкой делиться). А ты мог "типа" фармить опыт и качать репутацию с тамошним коллективом. Но, нахуй надо. Мазохизм и выслуживание.
А в стационаре можно проводить более сложные плановые операции. Челик сидит на приеме в частной и набирает клиентуру, например на ВЛС грыжи, ташит их в обычный стационар, где есть аппаратура, оперирует и получает гешефт. Смотря как у вас отношения выстроены в больничке, делится с кем-нибудь. Или ни скем, пошли нахуй.
Идешь на часть ставки в полку, направляешь к самому себе все грыжи, карбункулы, абсцессы и пр., оперируешь их там сам или со старшими товарищами, получаешь часть гешефта.
В Московской области это введено как обязаловка для зав х/о.
>нахуя ты в пикрил помойку рвешься
Так в Германии примерно такая же картина в крупных городах.
Даже в Москве и СПб уже сейчас половина новорожденных это дети мигрантов. Через 20 лет white birth не будет нигде.
Ну и если мы возвращаемся к медицине всё таки: в США, конечно, объективно лучше ФРГ (но не CH, всё таки), но тоже не мёдом намазано - реальная медиана для врачей там 'всего лишь' 240к в год, и это с их отвратительной рабочей этикой и отсутствием любого welfare. И разумеется, новые законы всё ну прям очень изменили: какой смысл теперь играть в эту лотерею, если можно будет туда поехать уже с опорой в виде немецкого паспорта, немецкого опыта и серьёзных накоплений?
>примерно такая же картина
Она не такая же как минимум потому, что те, кого в ФРГ относят к Asian (арабы, евреи), в США относят к White, то есть если применять к Германии американский стандарт, она будет буквально 95% White, за вычетом 2% негров и кучки реальных азиатов. Это мы ещё не говорим про то, что немцы до сих пор отделяют европейских мигрантов (славян, итальянцев и т.д.), которые часто тоже не совсем белые: в итоге в США тех самых англо-германцев, которые эту страну строили и которых полвека назад было большинство, осталось дай бог 20%. Как-то так.
>даже в Москве и СПб
Почему 'даже'? В РФ вообще полная дружбонародия, тут никакие расы или тем более migration background даже близко не проверяют.
>не будет нигде
Очевидно, везде будет 'корректировка', но кто-то просто станет чуть-чуть темнее и кучерявее, а кто-то просто вымрет.
Я как бы сам надеюсь, что у США-куна всё получится, потому что лучше пусть это место займёт мой славянский братушка, чем очередной Сакдип Дипщит, но это объективно не лучший вариант. Хороший, но не лучший.
Тебе тоже сил, упорства и удачи
5какой гешефт с абсцессов?
Никакого, ты их сам вскрываешь
Отделение больше оперирует - получает больше деняк из омс. И, если я правильно понял, хирурги могут получать процент с операций. За всех не знаю, но уролог в районе получает.
Какой нахуй омс и процент?
С больного за плановую операцию деньги берут и между собой делят.
Люди нищие.
Это если в омс работать так кажется, я когда в омс работал, ходил к бичам домой, ну нихуя мне повезло - дохтур аж 100к плюс имею!!! А как в частку, ДМС перебрался считаю себя услугой на обслуживании господ.
А в треде есть тяночки?
Где лучше? Какие вообще зп в частных и где лучше
https://ai.sechenov.ru/
Думайте
Думайте
все в треде - тяночки
Но я не тяночка..
Нищие люди с камушками в желчном пару месяцев ходят, а потом в очередь на плановую лапароскопию становятся за 150к.
Зачем, если можно получить бесплатно по программе гос гарантий...
https://emedici.com/
оставлю чисто для себя ссылочку тут
оставлю чисто для себя ссылочку тут
Ну в омс я скорее всего уже не вернусь)))
Но все очень сильно зависит от места и твоей "популярности", нет условной стабильности, потому что зависишь от процента, граффик не всегда нормированный как гос. Учреждениях, будешь работать на выхах праздниках, по доходам можно и просесть если записи не будет, но можно зарабатывать и больше если много трудиться и иметь поток. Но зато нет всего головняка ОМС, и пациенты приятнее и проще
Что из себя аспа по орг.здраву может представлять? Это прям на кафедре надо широебиться будет? пары вести? или лениво приходить сдавать экзамены и писать работу? Помниться тут был анон с кафедры орг.здрава, расскажи как у вас обстановка
Тред умер нахуй.
Как и медицина. Нахуя учиться на врача, если с 1 сентября тебя заменят фельдшером и ещё больше задампят твою и без того низкую получку.
В этом и была цель серунства дурачка илюшки тракториста
Модератор слишком поздно начал тереть политачерский дискурс про рашку парашку и швитой запад
Мужики, такой вопрос, а аккредитационный тест ежегодно меняется или вопросы те же остаются? Есть ли смысл начинать прорешивать его за год, или все равно поменяют вопросы?
Попутно добавляют новые и меняют, но немного, может соточку где-то. Так что нарешивать за год смысл есть.
Чел, их за неделю можно выучить особо не напрягаясь. Если напрягаясь, то за дня 4 с утра до вечера на 95-100. Какой год нахуй?
Ну не учись, документы забрать можно всегда, что сказать то хотел? Заебало это нытье.
Терпиггер.
Напоминаю
Кто нибудь занимается фарсом отзывов на продкоторов? Делитесь лайфхаками. Самому тошно выпрашивать оставить отзыв или напоминать об этом пациенту, хотя все мы спокойно относимся к отзывам и оценкам, когда посещаем рестораны/отели/такси, почему так?
Потому что у тебя нарцистичное самомнение, желание чтобы тобой восхищались и очень хрупкое эго. Ведь твое мнение о себе строится из одобрения/не одобрения окружающих. Ты боишься разрушить свой образ в чужих глазах если вдруг скажешь про О БОЖЕ МОЙ отзыв в интернете
Зачем же ты его так приложил.
Да я просто такой же
Как получить максимум баллов для бюджетной орды? Кому не сложно, скиньте весь список, что дает баллы, и что нужно делать?
Волонтерство? Сколько часов, и в каком формате?
Красный диплом?
Что еще?
Волонтерство? Сколько часов, и в каком формате?
Красный диплом?
Что еще?
Т.е. только волонтёрство в сфере здравохранения? От 300 часов, и 2 года минимум. Донорство туда не входит? (На сайте добро.рф оно есть, но в часах же его не посчитать?)
Получается, волонтерство, красный диплом, ну и работа на участке. Все? Или еще что-то есть
Зарин
На сайте шараги, куда поступать собираешься, посмотри
Где блядь работать будучи ординатором? Думал в приемку куда нибудь устроиться, на всех вакансиях пишут доп образование ординатура/интернатура по специальности терапия. На участок идти это же пиздец, про учебу можно забыть.
Я медбратом на помойке работал, потом начался ковид и устроился "врачом-стажером", а потом еще вторая волна подошла. Рекомендую зп была от 90к до 400к срублей.
Ща вместо ковида сво. Тоже неплохо по деньгам. Но там сложно совмещать с учебой
Риски чутка другие, да и учитывая курс срубля не так выгодно
Похоже на проблемы дс.
Мимо из мухосранска, где в приемнике никто кроме ординаторов и не работает причем 1 года
Мне всю ординатору пришлось работать там же где студентом + подрабатывал на профосомтрах от случая к случаю, потому что я ебал работать в приемнике/на скорой/участковым. Только на втором году за счёт счет стажерства смог на постоянку на профосомтры устроиться, ну и продолжал также дежурить, чтоб денег больше было..
Ну ты сравнил.
1) СВО только в приграничных городах или на т.н "новых территориях", а в ковид можно было работать в своем городе. Тут же как вахта по сути.
2) Совсем разные риски. Молодой и здоровый в ковид рисковал максимум пневмонию получить, если без казуистики. Тут же все понятно, хотя госпиталя особо и не бомбят.
3) Ты цены, инфляцию, и курс видел? Сейчас даже 100 и 200к не такие большие деньги.
Можно в москве вкатиться в военные больницы. Можно вкатиться в проведение, или организацию конференций по повышению грамотности как лечить и что делать с осложнениями боевых ранений.
Регулярно проходят среди практикующих врачей и студентов.
Там за одно такое мероприятие несколько лямов рублей утекает в разные руки. Надо их только подставить
Тащмайор, план выполняете? Лучше расскажите, как получить ВУС врач??? Только без абстракции и без знакомых из интернета, которые туда поехали рядовыми, а потом им сразу повышение давали и капитана, и кошкожену... Нахуя мне санитарить на передке? Я зачем вуз с ордой кончил? Стать кормом для личинок П'хы?
Если расскажете, я в пн буду у порога военкомата с пакетом документов.
Кто-нибудь может подсказать где можно курсы по пат физе достать ?
Проще всего закончить военную кафедру и получить офицерское звание во время учебы в медвузе, вариант ныне недоступный. Закончить ВМА, реальнее всего сейчас. А так да, двигаться по званиям прям с низов до офицерских. Знакомый дослужился до начальника медпункта на СВО, начинал с днища с сертификатом медбрата, причем у него даже вышка была неоконченная, сказали для офицера медслужбы нужно доучиться, в СПбМСИ после перезачета шараги и младших курсов медвуза год с лишком доучивался, доволен как слон
Сначала надо определить свой бэкграунд. Если не служил и 30 нет, и брони нет, то на свой страх и риск.
Никакой учебы не надо, идешь в свой военный стол при больничке где пашешь либо сразу в ВК, там на прием, к кому хз, можно сразу военкому, говоришь что хочешь стать офицером запаса, сдаешь документы, фотографии, проходишь медкомиссию и вот тебе ВУС врача, другое дело что для нее нужна ординатура ибо после вуза если ты не забыл ты хуй пойми кто врач-лечебник, а такой нет специальности у вояк. Кстати про зону сво, терапилы там будут на уровне как раз санитаров, знаю чела оттуда узкого спеца, служит вроде смесью санитара и медбрата, нахуя это нужно не знаю. Ещё знал одного из Вагнера, но теперь к ним вкатываться если в Африку только.
А думать нечего, я кстати думаю что движет зумерами идти в мед, это же не модно, а родителей что туда пихали они научились посылать нах.
Они из Африки уходят
Так, ну вроде определился, в лоры пойду, но за 6 лет ни шва не связал ни руками ниче не делал. В орде научат? Или хотя бы может в лоре узлы не надо вязать?
Это из Мали, есть ещё другие объекты.
Охуеть ты даешь, может на терапию тогда?
А че даю то? Я отработал два года в узкой хирургии ессно ниче делать не давали, шо в лор что в офтальм все нулячие идут я так понял и с бухты барахты
Да не охота на терапию, там коморбидные все, иб толстые заебистые. Ну еще психиатрию рассматриваю
сдал госпед сегодня, последний экз в этом ебучем универе
Дальше ещё будут в ординатуре, не ссы
там по любви
Скоро выпуск, вентилировал тему по работе в приемке. 4 ночи 4 суток зепка 42к
Пипяо
Пипяо
Дс, медсестра 1/3 сутки. 7 дней в месяц 110к+ инфекционка
Недавно вентилировал тему
Ахуй, в моем мухосранске за 35к ебашат студенты на ставку медсестры.
ебанный дс
Дс, санитар 1/3 8 часов. 7 дней в месяц 220к+ неврология
Недавно вентилировал тему
Не пизди
В ДС у тебя и поступлений будет 300+ за сутки, постоянные взъёбки у старшей/зава за любые косяки и отслеживание за сколько минут ты спустишься к больному и как с ним разговариваешь, в то время как в Мухосранске в выходные может и 0 быть поступлений.
Да. В той инфекционке на 3 медсестер 60 пациентов. Иногда на двоих
Какая зарплата у фтизиатров с учетом вредностей доплат мб и есть ли ранний срок выхода на пенсию как у аир и хирургов?
У нас в миллионнике около 75к, работают до 13.30
Узкие спецы в стационарах полтос получают, к слову
>Ну еще психиатрию рассматриваю
Тоже думал в сторону психиатрии, немного прихуел: зарплата маленькая, левака нет, льгот нет (только у среднего медперсонала). И да заёбанности там тоже хватает.
Пацаны, для тех кто мыслит стратегически и как раз лето-время выбора ординатуры, подсвечиваю тему: идите в ВОП. Будущее за ними, через 10 лет никаких кардиологов, гастроэнтерологов и прочих искусственных разделений в поликлиниках не будет, только для сложных случаев типа заёбистых аритмий, кардиомиопатий, ВЗК, ИЗЛ и прочего, и само собой в столице региона. Стационары тоже под снос, койки сокращают с каждым месяцем. Никаких ДЭПнутыэ бабок на чистку сосудов в неврологическое отделение, максимум дневной стационар им выделят. Все мемные учтеры привыкшие спихнуть ГБ ФП кардиологу, астму-хобл пульмонологу, язву-запор гастроэнтерологу, диабет эндокринологу, хондроз-боль в голове неврологу и тд и тп спихнутся сами на помойку. Оставят фельдшеров для хуйни типа соплей, дорсалгий, справок в санаторий и ВОПов для более сложных случаев. Я сам раньше думал что врачей-то уж не тронут, но это от создателей той пикчи-списка-вы на этом месте: «ну в жопу-то ебать не будут». Но тренд такой что ни за кого не держатся, ездил кто из врачей в Курскую область об этом знают, ну эту тему не стоит вскрывать, кто был и общался с человечками тот поймет о чем я.
Бюджеты не резиновые, митинги за сохранение ставок собирать не будут тоже, прогреют народ что только выиграют. Думайте.
>стратегическое планирование
>воп
Ты пьяный чтоли)) Если ты хочешь стратегически мыслить, то надо уебывать просто.
лоров то лоров оставят?
А то чето почитал в телеге всякие разные чаты там Лоры тоже бугуртят что не берут в городе в стацик, настолько не берут что отказались исполнять целевое и рокировку сделали ехай в район
Хотя их как бы дефицит
>подсвечиваю тему: идите в
Почти угадал. Думай дальше.
Айти? Морячка?
>уебывать
В айти или в моряки? Если тебе пох на 8 лет учебы то мне и уверен, что другим, нет.
Может еще какие-то варианты есть?
Ах ты сладкий пирожочек. Красава
Ехать в район +50к путинских лутать
Каким образом. Язык учить не хочу, это годы
Я по русски запоминают с труд ом
Кто-то сталкивался с таким? Поступаю после колледжа по вступительным. Одна тянка с группы вуза написала (я кое-что спрашивал в этой группе)- говорит ей посоветовали, те кто поступали,уже учатся, человека, он продает за 10к один экзамен, ответы и все варианты.
Думаю, пройду на платку. Но на бюджет, уверенности нет..
Реально ли такое, или развод? Как-то гарантий нету..
Думаю, пройду на платку. Но на бюджет, уверенности нет..
Реально ли такое, или развод? Как-то гарантий нету..
Че то на разводку какую то похоже. А где гарантия, что после того, как ты деньги переведешь, тебя в чс не кинут?
Ты нацпредатель, тебя накажут за то что ты родину предал
Через Германию перекатывался или сразу туда? Было ли что-то как в этом посте ? Есть другие подводные? Сколько получаешь?
А, и главное забыл: диалекты учил?
Какие диалекты, ты дебил? Никто не учит диалекты,немцы их сами не знают. Хох дойч и то гемморой выучить
Вот что писала тянка с группы.
У чела этого фотка фейковая (там мужик в костюме)-яндекс ее находит. По истории, страница азербайджанина какого-то была в году 2013+-. Т.е. страница старая. Ну понятно, если он работает в вузе, то фотку свою палить не будет. Ну и мужик в костюме-типа профессор, препод, чтоб люди более доверяли.
Пик1 тян писала в самом начале.
Пик 2 сегодня ей пишу. 4ое сообщение ее.
Пик 3-последнее что написал мне этот мужичок.
Насколько я помню, вступительные в вузе в 20ых числах июля.
Или еще и в июне есть? Или он спалился, т.к. не знает когда вступительные?
Какая вероятность, что кто-то из учащихся подтвердит, что он не кидала, если напишу нескольким из группы вуза? Или даже если кому-то он помог, не захотят рассказывать?
>немцы
На пикче швейцарская карточка.
>гемморой выучить
Ну ты тупой значит.
Я в Германии, а не в Швайце. Соответственно диалекты учить мне не пришлось. ЗП когда как, обычно 4500-5500 (чистыми).
Рад стараться.
Понял, спасибо. Интересно, почему тогда французский на карточке.
Так там даже по русски написано, просто на фоткк срезано
И что? От этого не легче выучить. Вообще учить чей-то тяжело, прочитал раз пять и как будто не читал какой блядь немецкий, поэтому выучить чето нереально
В одно ухо влетело в другое вылетело
Братик, если ты так на медбрате косячишь, то тебе в лоры нельзя
Почему
Кто-то или чьи-то знакомые вкатывались в работу в военные госпитали (нет, не на границе и не на СВО)? Какие подводные камни, что по доходам? Невыездной статус и не пугает если что.
>Какие подводные камни
Может уебать ракетой
Расскажите плез базу по поступлению в этом году. Говорят места дополнительные урезали, и доп. набора в августе не будет?
Проходные баллы не повысят?
Есть тут те, кто на платку поступал? Стоит того?
Проходные баллы не повысят?
Есть тут те, кто на платку поступал? Стоит того?
Не стоит, а рискуешь даже отучившись на платке, после поехать по распределению в залупу.
Ну и всю отрасль скатили в говно. С каждым годом все хуже, но мы уже по уши в этом говне и деваться некуда, а ты молодой, зелёный лучше вообще обходи стороной.
Комерциягоспода:
>Никуда не едут, никому не должны.
>Выбирают стомат, кардио, дерматологию, пластику.
>Открывают кабинеты, окупают обучение в первый год.
>В отличии от бомжей на бюджете.
Бюджетник:
>Оформляет на мсэ полубомжей на Колыме.
Зато не заплатил за обучение.
>Он еще не понял, что плата была не в ржублях, а в человеческих душах. И он продешевил.
Based или кринге?
>Никуда не едут, никому не должны.
>Выбирают стомат, кардио, дерматологию, пластику.
>Открывают кабинеты, окупают обучение в первый год.
>В отличии от бомжей на бюджете.
Бюджетник:
>Оформляет на мсэ полубомжей на Колыме.
Зато не заплатил за обучение.
>Он еще не понял, что плата была не в ржублях, а в человеческих душах. И он продешевил.
Based или кринге?
Туда катаются на вахту без контрактов в приграничные. Конкретно как, с кем надо обкашливать - хз.
Можно и с контрактом. Как пишут, врачи заключают на 6 месяцев, туда и обратно. Я бы скептически относился к этой инфе. Гречу с контракта не отпускают вообще, до победного там остаются или до гроба. Мб это замкнуха тупейшая и врача не уволят с него, если заключил.
Туда катаются на вахту без контрактов в приграничные. Конкретно как, с кем надо обкашливать - хз.
Можно и с контрактом. Как пишут, врачи заключают на 6 месяцев, туда и обратно. Я бы скептически относился к этой инфе. Гречу с контракта не отпускают вообще, до победного там остаются или до гроба. Мб это замкнуха тупейшая и врача не уволят с него, если заключил.
Учтер, поддс2. Подскажите плес, коллеги. Нихуя не умею считать и назначать инулины, всех СД 2 типа даже не впервые выявленных с гипергликемиями 13+ шлю по 057 в эндокринологический стационар. Запись к ближайшему эндокринологу амбулаторно через нахуй месяц. Вызываю этим бугурт эндокринологов и руководства, типа учтер обязан уметь лечить всех с СД 2типа и нельзя создавать такую нагрузку на стационарное звено. А я ебал брать на себя ответственность оставлять человека 13+ дома, перезаписывать к себе и чот там ему считать, не зная этой кухни нихуя. Я прав или нет?
мне 23 лвл будет в конце года.
планирую взять кредит под 3% с гос поддержкой. 300к в год.
а два кредита дают? Типа через 6 лет взять второй на орду, не выплатив первый?
А ты уверен, что будут платные места? Сейчас много где орда вообще целевая полностью. Даже за бабки не возьмут.
Хотя можешь после обучения оплатить и не отрабатывать
дай им алоглиптин и метформин хз
Не уверен. Но и сравнивать, судить не с чем. В том году-были. Даже "доп. набор" был. Где у 1 чела последнего балл по 1 предмету ниже МИНИМАЛЬНОГО проходного. 48, вместо 49.
> Сейчас много где орда вообще целевая полностью.
Ну орда это ладно, еще целых 6 лет, если поступлю. Сначала волнует специалитет. Я бы и на целевую согласился, при условии, что буду работать по специальности, полученной на орде, а не учтером
Все эти косметологини со своими кабинетами в итоге вышли замуж сразу после или во время ординатуры, родили и сели на шею мужу. Открыватель лол, ты хотя бы теорию изучи по банальному лицензированию специальности первичной медпомощи в госучреждении.
>Оформляет на мсэ полубомжей на Колыме.
Люди ходят на работу внезапно за зарплатой, я сам в ковидных временах (эх молодость) нихуево въебывал на участке, но и бабла поднял зато.
>а в человеческих душах
Ты че несешь, куда санитары смотрят?
>обязан уметь лечить всех с СД 2типа
Это так, диспансерное наблюдение тоже учтер осуществляет. Набирайся опыта хули, другое дело нужен гликемический профиль, hba1c, и прочее дерьмо.
Можешь мягко подталкивать чтобы шли в платку и там им корректировал эндокринолог.
А вообще ты только выпустисля или давно (сколько) РАБотаешь? Если первое то это проблема твоего завполкой, пусть попросит консультировать тебя по телефону эндокринолога, помогает записать и т.д.
>алоглиптин
Там речь про инсулины идет, так-то их надо обучать нормально в школе диабета, просто они все нажираются и ебали что-то там считать ХЕ, калории, единицы инсулина.
Работаю 11 месяцев учтером. Д наблюдение как раз изи - приходит бабуля, я даю ей анализы гликированный и глюкозу, чекаю, оам, креатинин, ноги смотрю - ну и если всё ок, то вот оно д набл
Другое дело, если не ок и если вижу в гликированном нахуй 10 а в глюкозе 13-15, не понимаю, как учтер может ещё и с этим ебаться за свои 12 минут приёма и не отправлять в стационар а брать на себя ответственность какие то там глиптины выписывать и с тяжёлой гипергликемией домой до следующего раза отпускать
Ебать забористый копиум. Просто wageslave выдресированный. Давай еще штамчиков понюхай повидлы и шмурдякнись.
>Ты шо ахуел тут частный прием вести и на шею садится ай-яй-яй!
За участок! За больных! За главнюка! За минздрав! ГОЙДААААА!
Ля, чел, это такой пиздец. Такая кабала просто несусветная. Зп у коновалов бывает разной, это правда, но не настолько ахуенной. Олсо, сама мысль - кредит на медобразование в стране, где тотальный дефицит в медицине всего и вся. Нахуй выворачивает.
На твоем месте, я бы не очковал и пытал счастье на бюджете. Даже с условно средними баллами. Когда поступал сам, у меня был оверкил по баллам на бюджет, но когда отсеялись высокобальники и залетухи, показалась реальная картина с 2 и 3 донабором на бюджет. Пиздец просто. Такой скам прошел на фри.
Попробуй узнать о фишке с переводом на платное на последнем курсе. Или узнать про целевое на орду или кредите на орду на крайняк. Но не на 6 летнее основное. Это пиздец.
Олсо, выбирай признаваемый вуз и списка wdoms.
На второе высшие нельзя бюджет
Вообще не иди сюда. Сфера полный кал. Выкатываться точно не стоит. Я вот только орду закончил - чувствую что проебал 8 лет жизни на полную хуйню.
Почему. А где еще работать? Чем заниматься, 8 лет в стену смотреть?
Я не знаю. у меня 2 варианта. Кредит под 3%- 6 лет по 1к в мес платить, потом после 6 лет+9мес 12к в мес. Кредит на 15 лет, могу раньше закрыть. Если не раньше переплата 400к. 1.8кк обучение+400к.
Или целевое, но в конце отказаться и буду должен сразу после отказа-окончания обучения 1.8кк
Но я не знаю как отказываться и можно ли, и какие последствия?
П.с. я поздно начал готовиться, т.к. не уверен был в направлении, выбирал между 2ух зол. Мне 23 в конце года. Еще год сидеть ради "попытать удачу на бюджет"-не вариант.
Лучше заплатить и поступить в этом
>Ля, чел, это такой пиздец. Такая кабала просто несусветная. Зп у коновалов бывает разной, это правда, но не настолько ахуенной. Олсо, сама мысль - кредит на медобразование в стране, где тотальный дефицит в медицине всего и вся. Нахуй выворачивает.
ну платить будут родители не я
>На твоем месте, я бы не очковал и пытал счастье на бюджете. Даже с условно средними баллами.
>Олсо, выбирай признаваемый вуз и списка wdoms.
На бюджет проходной 250+. Я в лучшем случае 200 наберу.
Ну я рассматриваю местный МухГу. В другие города не поеду.
Я же не выбираю сначала, как поступать, на платку, или бюджет? Конкурс общий, и если не пройду на бюджет, мне предложат на платку? Или сразу говорю-я на платку? А можно и на бюджет и платку податься, если не пройду на 1, пойти на второе?
>Попробуй узнать о фишке с переводом на платное на последнем курсе
Можно с платного на бюджет перевестись. Но в этом году, места были лишь на 2ом семестре 3ьего курса. Т.е. половину за все обучение придется заплатить.
Я после калледжа+год с военкоматом решал дела. А когда решил- уже поздно было поступать, т.е. еще 1 год просидел.
Но это единственное, что мне интересно. Даже если вдруг работать не буду-мне интересно там учиться.
Или целевое, но в конце отказаться и буду должен сразу после отказа-окончания обучения 1.8кк
Но я не знаю как отказываться и можно ли, и какие последствия?
П.с. я поздно начал готовиться, т.к. не уверен был в направлении, выбирал между 2ух зол. Мне 23 в конце года. Еще год сидеть ради "попытать удачу на бюджет"-не вариант.
Лучше заплатить и поступить в этом
>Ля, чел, это такой пиздец. Такая кабала просто несусветная. Зп у коновалов бывает разной, это правда, но не настолько ахуенной. Олсо, сама мысль - кредит на медобразование в стране, где тотальный дефицит в медицине всего и вся. Нахуй выворачивает.
ну платить будут родители не я
>На твоем месте, я бы не очковал и пытал счастье на бюджете. Даже с условно средними баллами.
>Олсо, выбирай признаваемый вуз и списка wdoms.
На бюджет проходной 250+. Я в лучшем случае 200 наберу.
Ну я рассматриваю местный МухГу. В другие города не поеду.
Я же не выбираю сначала, как поступать, на платку, или бюджет? Конкурс общий, и если не пройду на бюджет, мне предложат на платку? Или сразу говорю-я на платку? А можно и на бюджет и платку податься, если не пройду на 1, пойти на второе?
>Попробуй узнать о фишке с переводом на платное на последнем курсе
Можно с платного на бюджет перевестись. Но в этом году, места были лишь на 2ом семестре 3ьего курса. Т.е. половину за все обучение придется заплатить.
Я после калледжа+год с военкоматом решал дела. А когда решил- уже поздно было поступать, т.е. еще 1 год просидел.
Но это единственное, что мне интересно. Даже если вдруг работать не буду-мне интересно там учиться.
Отработал медбратиком. Очень устал. Нет времени ни посрать не поесть.
Очень очень очень очень очень много пациентов
Как орда по лору проходит? Руками объясняют. Че делать?
как скипнуть практику летнюю? ваще желания нет нахуй нет после экзаменов
Тупо спрашивать. Орда это чистый рандом, который зависит от места прохождения, руководителя. Лучше спрашивай уже у ординаторов в том месте, куда собираешься поступать.
Тупо не ходить, как самый экстремальный вариант. Потом осенью что-нибудь придумаешь с деканатом.
Ну ещё смотря где практика. Зачастую студенты никому нахуй не нужны и хождение тупо добровольно, очень редко когда попадается кто-то идейный или наоборот желающий тупо скинуть всю работу.
Как правило практику подписывает кто-то старший по отделению и ему будет глубоко насрать на посещаемостью он следить не будет. Придёшь тупо в первый и в последний день.
Если будет возможность выбирать в больнице: не выбирай самые очковые места, где точно будет работа. Бери какие-нибудь тяжёлые с точки зрения технологии отделения, вроде нейрохирургии, где ты тупо никому нахуй не нужен будешь под рукой мешался.
Не слушай рапиздяя, это обязательная часть учебного плана, если не принесешь подписанные бумажки с печатью, тебя обоснованно отчислят, такие долбоебы регулярно отлетают, в лучшем случае заставят посещать во время семестра, сам понимаешь чем это чревато. Договаривайся на месте, все зависит от конкретной старшей медсестры или заведующего отделением, узнавай где всем похуй и иди туда
Алсо, в хирургии всегда есть лежаки, которых нужно таскать, стремись в хуйню типа лоров, офтальмов или рентгена шарики катать
можно ли с целевого перевестись на бюджет? Или если подписал-то ждать конца учебы и отказываться-оплачивая фулл стоимость? А перевестись на начальных курсах, и оплатить лишь то, что проучился, как на платке/кредите?
Перевестись нельзя. Можно только отчислиться и восстановиться на платку, тогда зависит от договора, заставят тебя просто заплатить стоимость пройденных курсов или со штрафом
Оба твоих варианта хуйня. Запомни - медицина либо для умных (чистый бюджет), либо для богатых, когда ты на расслабоне будешь спокойно учиться, снимать хату, ебать однокурсниц и собираться в свободное время бухнуть с друзьями. Когда тебе не нужно работать, не нужно бегать по отработкам и пересдачам, только так можно стать нормальным врачом. Смирись с этим и выкинь из головы всю эту инфантильную хуйню типа "мне нравится толька эта сфера, ничего другова не хочу)". Да, жестко, но я вкину спойлер, что тебя ждет, если не последуешь совету:
1) 90% числанут на первых 3х курсах. Нет, не преувеличиваю и не нужно думать, что ты какой то особенный и тебя это не коснется. Почему? Потому что ты инфантильный паренек, судя по возрасту, вопросам и тексту в целом. Столкнувшись с реалиями ты не вывезешь. И да, я видел много людей 23+ на первом курсе. Знаешь сколько из них доучились? 2, и то там свои нюансы, ты к ним не относишься.
2) 10% Условно тебе повезет хотя наоборот и ты чудом закончишь. С долгом в 3ляма+ да да, стоимость обучения увеличивается каждый год и к концу твоего обучения 6 курс будет стоить в 2 раза дороже чем первый в лучшем случае, а оплатить сразу все нельзя - только за ближайший семестр/курс. И ты, 30 - летний лоб с бумажкой пилюлькина, огромным долгом и возможностью получать зп чуть выше среднего в твоей мухосрани, претендуешь на ординатуру.Даже если 6 лет тебе будет удаваться сидеть на шее у нищей мамки, которая возьмет оплату кредита на себя (не забывай, что тебе еще где то нужно жить и что то есть), что будет потом - неизвестно. 6 лет большой срок, намнооого больше, чем кажется, который ты проведешь в нищете, унижениях, выгораниях, после которых ты еще и собираешься учиться дальше. И все это время ты будешь наблюдать белых людей рядом с собой, с которыми ты вряд ли найдешь общий язык, которые живут на чиле, из хороших семей, которые будут смотреть на тебя как собственно и ты на себя, как на долбаеба.
> да да, стоимость обучения увеличивается каждый год и к концу твоего обучения 6 курс
После заключения договора оплата не растет остается такой же как при поступлении
> огромным долгом
2 ляма это копейки
> Ну я рассматриваю местный МухГу. В другие города не поеду.
Почему, нахуя
мимо
Поясните, нахуя нужен терапевт в век нейронок? Это я так понимаю те, кто не поступил на нормальные специальности?
База, этот шарит.
>2 ляма это копейки
Ага, с зарплатой в сотыгу, вообще хуйня, всего 20 месяцев не есть не пить и можно отдать. Вы в каком мире живёте?
Нейронка не обладает субъектностью. Не может открыть больничный, направить на мсэ. Нейронке не дашь взятки и не пососешь из неё кровь.
>смотреть на тебя как собственно и ты на себя, как на долбаеба.
Почему
Ну не знаю у кого там зарплата в сотыгу, но отдать 2 ляма кредитных не сложно, тем более он субсидируется гос-вом. Его не обязательно гасить полностью, только снизить сумму платежа в месяц ну с 15к (которые будут у анона) до ~5к. А для этого надо всего 500к сверху закинуть в рамках досрочного платежа.
>когда ты на расслабоне будешь спокойно учиться, снимать хату
Я хату и буду снимать. Работать не буду-ток летом. Родители будут оплачивать. Кредит-там 1.5к в мес. До конца учебы +9 мес. Только потом он станет 12к в мес.
> 90% числанут на первых 3х курсах
Я реально долго думал, и это прям моё, чувствую. Может числанут может еще что-то. Но тут я прям буду учиться, не потому что нужно, а потому что нравится.
>С долгом в 3ляма+
Планирую просить у родителей, но на вклад. Т.к. кредит.
Будет под 16-20%. И к концу обучения сразу все оплачу+ останется, мб на первоначальный взнос на ипотеку, хз
>И ты, 30 - летний лоб
Я закончу в 28лвл, 29 мне будет в конце года, в котором закончу.
>огромным долгом и возможностью получать зп чуть выше среднего в твоей мухосрани, претендуешь на ординатуру
Долга не будет, сразу оплачу. Да, зато работа не руками, и это того стоит. Но вообще, я прям горю, по некоторый специальности на орде.
>которая возьмет оплату кредита на себя
Ну я у родителей и попрошу. В конце, либо % себе заберут, либо мне на первоначальный взнос.
>который ты проведешь в нищете, унижениях, выгораниях
Что такое нищета? Вот квартиру среднюю за 20к+- найду. Работать не буду. Всё. Всякая техника, рестораны-мне не нужны. Если что-летом поработаю, на свою хотелку наработаю.
>с которыми ты вряд ли найдешь общий язык, которые живут на чиле, из хороших семей
Не все на чиле. Не малая часть из других городов, кто-то в общаге, кто-то снимает квартиру. И многие работают.
Мне вышка необходима. Я на дноработу не пойду. В теории, мне пофиг на долг в много лямов, с меня ничего не взять, на меня ничего не оформлено. Либо вышка (желательно интересная) либо ркн в 30лвл.
>Почему, нахуя
Потому что это мой город. Я егэ знаю, он не совсем мухосранск, я радом живу, рядом мой дом. Переезжать в больший мухосранск желания нет.
>Ага, с зарплатой в сотыгу, вообще хуйня, всего 20 месяцев не есть не пить и можно отдать. Вы в каком мире живёте?
Его дают до 15 лет. под 3%. Не как сейчас кредиты под 20-25%. ПОД 3%.
1.8кк учеба, и до 2.2кк переплата за все 15 лет. Если раньше погасить-переплата будет меньше.
>сумму платежа в месяц ну с 15к
Не, там не так. Пикрил. Считай 1 шаву в месяц покупаешь, и не ешь.
Я сам не совсем с города, и мне нужна будет квартира.
Так что, да, буду жить 1 в съемной квартире, работать не буду.
>И ты, 30 - летний лоб
В штатах и гермашке же, во столько+- оканчивают?
Штаты от 29 лвла
Германия 30 лвл
Россия с 24
Но учитывай еще разную длительность школьного обучения
> Потому что это мой город. Я егэ знаю, он не совсем мухосранск, я радом живу, рядом мой дом. Переезжать в больший мухосранск желания нет.
Что за город? Я тебя полностью поддерживаю по всем вопросам кроме поступления в мухвуз.
Либо питер либо москва лиьо казань.
Ну я возле ДС.
>Либо питер либо москва лиьо казань.
Сомнительно Питер и Казань. Если на что и менять комфорт, то Москва. Но я туда вряд ли пройду, а если и пройду, то там ценних х2-3 на обучение, х2-3 на квартиры
Так что за город
>Я реально долго думал, и это прям моё, чувствую. Может числанут может еще что-то. Но тут я прям буду учиться, не потому что нужно, а потому что нравится.
> Да, зато работа не руками, и это того стоит. Но вообще, я прям горю, по некоторый специальности на орде.
Собственно поэтому я и сказал, что ты смотришь на это с детской позиции. Тебе не может нравиться и ты не можешь гореть спецухой/медом, потому что твои представления об учебе и работе - фантазии, далекие от реальности. Ты влюбился в образ медицины, а не в нее саму, столкнувшись с ней настоящей - сдуешься очень быстро
>Что такое нищета?
Брать кредит - стопроцентный признак нищеты. По крайней мере в России.
При коммунистах легко было устроиться санитаров в больницы, сейчас эту специальность уничтожили почти, а жаль, многое бы встало на места в голове и желание идти на эти галеры исчезло.
>Собственно поэтому я и сказал, что ты смотришь на это с детской позиции. Тебе не может нравиться и ты не можешь гореть спецухой/медом, потому что твои представления об учебе и работе - фантазии, далекие от реальности. Ты влюбился в образ медицины, а не в нее саму, столкнувшись с ней настоящей - сдуешься очень быстро
Нет, я знаю какие реалии. Что там не все как в сериалах.
У меня альтернативы нет. Я ботаю химбио. Биофак и химфак в мухгу-смешно. Есть треды тут, все без работы сидят.
Мне больше некуда идти. А это мне интересно.
>Брать кредит - стопроцентный признак нищеты. По крайней мере в России.
Каждый второй ипотеку берет и ничего. А тут всего 3%. Да я даже оплачивать 7 лет (6 и 9мес) не буду, онли проценты.
А потом, все может поменяться. Может меня не будет, может страны не будет, может я слиняю (актуально если и числанут). И много чего еще.
Да я даже оправдываться не хочу. Я же смогу сразу закрыть кредит, как только получу корочку.
Анон, если ты ещё тут: можешь, пожалуйста, рассказать, как там дела с транспортом?
Я только недавно осознал, что госпитали, внезапно, часто находятся вне доступности общественного транспорта, особенно в сельской Померании, а я вообще нихуя не водитель.
Получается, мне остаётся только пытаться пролезть в Дрезден или Лейпциг, если я хочу жить в европейской мечте с walkable cities?
Сап, как лучше медиктест учить по блокам или по тематике тестов?
Нужна ли химия в меде? Типа могут за нее отчислить, или там очень лайтовые задания, все изи списывается и прочее, и даже до егэ на половину не дотягивает? (Вуз не ДС1 и не ДС2 (мб влияет на строгость))
Мимо завалил химии егэ, надеюсь на вступительные..
Мимо завалил химии егэ, надеюсь на вступительные..
Ну у нас как было раз не сдал пересдача два не сдал пересдача, потом уже просто ставят тройбан за факт явки, ступайте
Вузу отчислять невыгодно и так врачей не хватает
>ступайте Вузу отчислять невыгодно
Даже если на платке?
Вообще химия не мое.. Ну базу понял слегка. Как называются вещества, связи, простые реакции, и немного другого. ВСЁ.. +могу задачи решать, если не сложные.
Если в вузе можно списывать, а не сдавать устно, или к доске вызывать не будут, наверно прокатит. Или будут?
А я вот обожаю химию.
Заканчиваю через месяц медицинскую биохимию и понимаю, что мне не интересна медицина от слова совсем, сегодня после защиты диплома появилось обсессивное желание поступить в аспирантуру в ИБХ или ИОХ РАН и продолжить заниматься наукой.
План практически нереализуемый, надо сдавать вступительные, но очень хочется, попробую отправить CV, посмотрим, может что выйдет путного из этого дела.
Заканчиваю через месяц медицинскую биохимию и понимаю, что мне не интересна медицина от слова совсем, сегодня после защиты диплома появилось обсессивное желание поступить в аспирантуру в ИБХ или ИОХ РАН и продолжить заниматься наукой.
План практически нереализуемый, надо сдавать вступительные, но очень хочется, попробую отправить CV, посмотрим, может что выйдет путного из этого дела.
> Если в вузе можно списывать, а не сдавать устно, или к доске вызывать не будут, наверно прокатит. Или будут?
Я учился в многопрофильном вузе, преподы были с настоящего химфака, причем одного из ведущих по стране, серьезная подготовка. Была физическая и коллоидная химия 1 семестр, органика 1 семестр, неорганика 1 семестр, аналитическая химия 2 семестра. У многих слетал колпак из-за такого дроча, но экзамены сдавали все, и преподы с пониманием относились к знаниям и способностям к так называемым "медикам" (студентам 1-2 курсов, их по-другому то и не назвать). На парах и лабораторных было тяжело, вызывали к доске, контрольные на каждую тему - на экзаменах лайтово спрашивали, за все вовремя сданное ставили автомат и отпускали.
Да мне тоже химия нравилась, но чтобы без матеши.
Там например hcl + h20 = cl + h30
Вот это понятно или там что такое naoh? Основание!!!
Вот нормально вот понятно , а физколодиная уравнение нереста константа михаэлиса. Вообще не понял че к чем, проходил на пересдачи в конце концов просто поставили
Блеать, так платников тем более западло отчислять они услугу купили
Факты, достаточно просто ходить и ходить на отработки и пересдачи и так поставят.
У нас например в конце семестра тестирование по всем предметам на компах в цнт под камерами, причем реально строго смотрят чтобы не списывали и не помогали друг другу. Прямо женщина сидит и чуть ли не матом орет если что то. Порог 70% иногда 85%. При всем этом когда уже идёшь на пересдачу этого же теста туда же, достаточно придти чтобы ты был 1 в кабинете, и эта же самая женщина любезно тебе надиктует ответы аккуратно до 70%, а дальше решаешь сам.
Тупой дроч 2 раза каждого кругляша по 100 вопросов 2 раза. Первый раз наобум, второй раз на результат. После этого у тебя сохранятся вопросы, где ошибался чаще всего. Их дрочишь отдельно. Поздравляю.
>Джва раза по джва раза.
В чем подводные пойти работать на вахту на медосмотр работяг? Зарплата там нормальная, делать вроде нихера не надо. Сиди себе жди смену с утра и вечером.... кто в курсе ?
В том что это вахта очевидно. Там и невврачам платят дохуя и даже больше. Водители получают 200к+
Алкоголизм. Холодно. Высокая концентрация орков.
Как же хочется обычную работу без переработок, ночных умираний и липовых осмотров с нормальными условиями труда и отдыха. Неужели я так многого прошу?
Что там нового с законом по отработкам? Я так понял, его де факто приняли уже.
что за закон
Ну очевидны минус уже что это вахта. Хотя работа врача там, конечно, в разы лучше чем у работяг.
Основной минус вахты в том, что межвахту тебе никто не оплачивает и поэтому ЗП надо делить не только на время нахождения, но и период между ними - уже не так красиво в месяц будет получаться. Условно, два месяца вахта два дома, оплата за вахту 400к - на деле выходит 100к в месяц, уже не так вкусно, да?
А ещё на работе ты несколько месяцев вообще без каких-либо выходных и даже времени после работы, ты находишься на работе всегда, все 24/30, или 24/60, даже если непосредственно нихуя не делаешь и лежишь читаешь книгу - ты все равно на работе, а не на воле. учитывая все вышесказанное, сколько по итогу получается час твоей работы?
Ещё смотря как вахту воспринимать. Если ты дохуя социально активен, бодр и жизнерадостен, то да, как будто не на воле, а постоянно на работе.
Если тебе уже на все похуй, ты выгорел в край, заебала семья или ещё что. То вахта как отпуск, накачал себе на ноут игр, сериалов, кинца, да чего угодно и поехал с кайфом. Если один в комнате живешь, что для врача не редкость, то вообще курорт. Еду готовить не надо, проблем с логистикой на работу, вставая за 2 часа до смены, нет.
На работе на похуй отсидел, заполняя однотипную хуйню, пришел в номер пешочком, зачилился. И так повторить. Опционально можно побегать вокруг поселения, пойти в местный спортзал. Если вахта ещё в живописном месте, летом, то вообще заебись.
Ну я в померании и живу. Тут с транспортом я бы сказал кхе кхе. Чем меньше город тем реже автобусы ходят и тем менее они заполнены (потому что селюки на машинах ездят). В ростоке или шверине всё норм, куча маршрутов автобусов и травмай в ростоке. В целом если тебе не хочется ездить на машине ездить, то можно на велосипеде на 99% потребность в транспорте закрыть.
>можно на велосипеде на 99% потребность в транспорте закрыть
Понял, спасибо.
Скажите плез по новым законам. В вуз планирую поступать идти на след неделе доки подавать.
На бюджет только 2 места. Так и будет до конца приемной кампании? Просто в том году тоже, несколько мест было. Но к концу кампании зашел, там несколько десятков мест было.
Но в этом году слышал в новостях, законы. Что не будет доп. приема на платку. И тут вы пишете, что бюджет заменят на целевое.
Так, ждать пополнение бюджетных мест?
А что по платке, какие отличия от прошлого года?
П.с. это мухгу.
На бюджет только 2 места. Так и будет до конца приемной кампании? Просто в том году тоже, несколько мест было. Но к концу кампании зашел, там несколько десятков мест было.
Но в этом году слышал в новостях, законы. Что не будет доп. приема на платку. И тут вы пишете, что бюджет заменят на целевое.
Так, ждать пополнение бюджетных мест?
А что по платке, какие отличия от прошлого года?
П.с. это мухгу.
Хуй знает про новые законы, но обычно невостребованные целевые места переводят в чистый бюджет.
Соответственно делают это после зачисления людей на целевое. Заранее хуй узнаешь, рулетка.
Но если в том году был перенос мест, то скорее всего будет и в этом, так как вряд ли за год резко появится больше целевиков, и при том же количестве мест на целевое хуй они их заполнят.
На счёт платки не ебу
Ну и добавлю, что для таких фокусов надо яйца иметь. Так как это все происходит уже после основного зачисления. Условно они зачисляют целевиков, платников и тех 2 чистых бюджетников. Уже после всего этого если остались свободные целевые места, они должны отдельно продлить сроки приема, перевести их в чистый бюджет и ещё раз зачислить в бюджет. Все это отдельными приказами и растянуто по времени, так что понервничать придется + нихуя не гарантировано.
В прошлом году "план приема" был 5 человек.
Но смотрю приказы о зачислении, там 39 человек на бюджете.
Но вы тут постоянно пишете, что бюджета уже не будет, сокращают бюджетные места, будут уже только целевые.
>Ну и добавлю, что для таких фокусов надо яйца иметь. Так как это все происходит уже после основного зачисления. Условно они зачисляют целевиков, платников и тех 2 чистых бюджетников. Уже после всего этого если остались свободные целевые места, они должны отдельно продлить сроки приема
Т.е. если подам заявление и на бюджет, и на договор, я не смогу дождаться дополнительного зачисления на бюджет, т.к. мне надо выбирать, либо оплачивать платку, либо надеяться на места, которых может и не быть ,а может не смогу пройти на бюджет?
Вроде, с этого года дополнительного набора на платке не будет? Получается, если рискну, и не соглашусь на платку сначала, уже после, не смогу поступить, т.к. второй платки (доп. приема) не будет?
Если баллы хорошие и денег нет, то подавайся бюджет если че поступишь в след году там результаты егэ действительны 4 года
>Места сокращают
Ну да, их сократили, раньше было условно 100 чистого, 100 целевого и 10 особой квоты. Сейчас 2 чистого, 40 особой квоты и 168 целевого, разницу чувствуешь? Только появился нюанс, что найти 168 рабов и 40 инвалидов очень сложно, и вуз вынужден переводить эти места в чистый бюджет, чтобы вообще хоть кого нибудь набрать
>Пролететь с поступлением
Зависит от вуза, сможешь ли потом на платку поступить. Вуз всегда может объявить дополнительный прием, продлить сроки приема и прочее, но вопрос сделает ли он это.
Но если не продлит, то да, можешь так пролететь. Попробуй позвонить в приемную комиссию и спросить, будет ли допприем. Только делать это надо уже под конец приема и как то хитро формулировать типо с другого города подаёшь, не успеваешь и тд, иначе тебе нахуй пошлют с такими вопросами.
Ещё в чистый бюджет переходят невостребованные места особой квоты. Всякие там инвалиды и военные. И таких мест очень много, так как считаются они в % от всех мест, вполне 30-50 мест, из которых дай бог только 10-20 займут, остальные спокойно пойдут в чистый бюджет.
И кстати это очень стрёмная тенденция, когда на целевое и особую квоту спокойно проходят челу с 130 баллами, а чел с 250 может вообще не поступить, так как из за этой хуйня с переносом может пролететь, отрицательная селекция хули. ебало пациентов представили от качества врачей в ближайшее 0-10 лет?
Допустим, в орду 1 целевое и 1 платное место. Я подаю доки на платку, если целевое не занимают, то меня переведут на бюджет? Или на бюджет попадет рандомный кабанчик на подскоке?
>Если баллы хорошие и денег нет, то подавайся бюджет если че поступишь в след году там результаты егэ действительны 4 года
Не хочется год терять, и так 8 лет учиться..
Баллы средние. Деньги-не то чтобы нету, но для семьи это большие деньги.
>что найти 168 рабов и 40 инвалидов очень сложно
А свошники и дети свошников, по другой квоте идут?
>Зависит от вуза, сможешь ли потом на платку поступить. Вуз всегда может объявить дополнительный прием, продлить сроки приема и прочее
Так новость весной была, что запрещают доп прием на платку проводить в медах
>И кстати это очень стрёмная тенденция, когда на целевое и особую квоту спокойно проходят челу с 130 баллами, а чел с 250 может вообще не поступить
Сейчас открыл список зачисленных в том году в мой вуз, там 249 балл бюджет минимальный, на основном приеме, и 241 на дополнительном.
Но на целевом есть человек с 282 баллами, основной прием. Зачем ему целевое?
>ебало пациентов представили от качества врачей в ближайшее 0-10 лет?
Так есть еще иностранцы, которые на бюджет поступают. И часть из них, уезжают из РФ. Могли бы лучше бюджетных мест гражданам РФ выделить, а иностранцам онли платку
Трясёшься - подавай доки в ДВ вуз. Там везде ниже 200 проходные.
всех приветствую, тут вопрос созрел, заебался учиться в своем вузе, хочу перекатиться в другой город, в обяз надо ехать в этот вуз показывать документы или можно через электронную почту. и где мониторить бюджетные места; вероятность бюджета мала?
Есть вузы где принципиально нет чистого бюджета и это место пропадет.
Кабанчик на подскоке, ты же на платку подал, а не на бюджет
>Завершение приема документов, необходимых для поступления: на бюджетные места по целевой квоте – 8августа, на бюджетные места по общему конкурсу–12 августа, на внебюджетные места по договору– 15 августа
Итого: подскакивать 11 августа (т.к. 9 и 10 – выходные)?
>ты дохуя социально активен, бодр и жизнерадостен, то да, как будто не на воле, а постоянно на работе.
Я не такой, обычный сыч по натуре, но даже когда работал на максимально рассосной работе, где 90% времени лежишь на диване, то все равно даже на просто суточных сменах чувствовал себя как тюрьме. Ты один хуй себе не принадлежишь: ты не находишься где нравится, не в родной сычевальне, нет под боком любимой пеки, не можешь прямо совсем что хочешь делать вроде уйти погулять, или уехать побродить за город на электричке.
Хуй знает как это объяснить, но в любом случае воспринимается не как воля, даже если нихуя делать не надо.
Какая химия нужна на леч факе?
Не прохожу порог по химии, трудно дается неорганика. Если заботаю органику, смогу шарить на парах? Там же наверно, одна органика будет?
мимо готовлюсь к вступительным
Не прохожу порог по химии, трудно дается неорганика. Если заботаю органику, смогу шарить на парах? Там же наверно, одна органика будет?
мимо готовлюсь к вступительным
Если посещу психиатра в частной клинике, меня потом возьмут туда работать? Или скажут у тебя проблемы, нам такие не нужны? Есть подобные кейсы?
На парах химии не будет от слова совсем
Зачем пиздишь
Может тебе туда просто не идти на прием и всё? Кстати, скоро мед системы объединят и похуй куда ты ходил, всех можно будет пробить.
Не пизжу
Если у тебя траблы с башкой, зачем тебе идти туда работать?
И так блядь каждый второй психиатр шизоид
что хуже, варикоцеле или 53 балла в егэ по химии?
Вариколеце
Химию пересдашь в след году
ну а варикоцеле удалить можно
Проблему надо решить.. А точнее мне нужны таблы рецептурные
>Если у тебя траблы с башкой, зачем тебе идти туда работать?
Потому что хочется и нравится? Главное не в госку, чтоб там карту не заводить и ограничений не было.
П.с. я с мухосрани, тут особо выбора нет, среди частных клиник.
>И так блядь каждый второй психиатр шизоид
Одно дело на словах. Другое с диагнозом и карточкой
Шизик бля
от учебы в меде у меня уменьшилось яичко. мнение???
от учебы в меде у меня расширилось очко.
ПОЯСНИТЕ за тесты на сам аккред.
Там реально будет пул новых вопросов, которых не было ни на ФМЗА ни на медиктесте? Есть варик того, что дальновосточные вузы сольют что-то из пула?
А как готовиться то нахуй тогда к этому? Кто-то говорит, что тест будет на 100% состоять из незнакомых вопросов, кто-то, что только 10% разбавят.
Там реально будет пул новых вопросов, которых не было ни на ФМЗА ни на медиктесте? Есть варик того, что дальновосточные вузы сольют что-то из пула?
А как готовиться то нахуй тогда к этому? Кто-то говорит, что тест будет на 100% состоять из незнакомых вопросов, кто-то, что только 10% разбавят.
Анест 12 лет стажа. Всем учащимся и поступающим в мед надо понимать что лет 5 придется впахиать за копейки. По специальностям где можно заработать - кардиология, травматология -ортопедия, дерматовенерология, вот пишу и думаю что в целом можно зарабатывать в любой специальности, только надо быть нормальным спецом и набрать клиентскую базу.
НЕМЕЦКИЙ ИЛИ АНГЛИЙСКИЙ ЧТО ВЫБРАТЬ АНОНЫ ХЕЛП
скоро иду подавать доки в вуз. надо выбрать какой язык изучать. Вуз норм, не шарага. Есть знакомая тян там учится, она норм язык знает, и говорит на пересдачи приходится ходить, хотя она даже понимает на слух английский.
сам я учил в школе немецкий. Ну как учил.. Не учил, но был немецкий. Знаю слов 20 в лучшем случае. И это с числами. Английский на таком же уровне.
Какой выбрать и почему? какой перспективнее?
поступаю в мед. потом хочу на психиатрию пойти (мб потом поменяется, но пока выбор такой).
если куда-то перекатываться, то не в сша. эта страна мне не интересна.
Да и в германию легче всего.
так же я нацист, и очень интересна история и творчество Германии до середины прошлого века.
Т.е. тут язык поможет.
Английский же-поможет в любой стране, как туристу. Или на первое время пребывания, если перекатываюсь. Так же на английском есть всякая литература, ролики, статьи, исследования. Фильмы в оригинальной озвучке.
Два варианта. Изучать немецкий в вузе, а второй (английский) в свободное время, очень вяленько.
Или наоборот. Английский в вузе, немецкий вяленько дома.
Не уверен насчет переката. Но если и будет-то не туда, где нужен английский (не штаты)
И вопрос. Когда выбирается язык. Сразу при подаче документов, или после зачисления? И можно ли его поменять, например, если при подаче документов выбрал, и до сентября изменить?
Вообще какой вы изучали, и есть ли тут те, кто выбрал другой, не тот, что в школе изучали?
Ну и последний вопрос, есть ли в мед вузах "начальные группы", где с 0 изучают языки? Чтоб не отчислили за неуспеваемость по иностранному
скоро иду подавать доки в вуз. надо выбрать какой язык изучать. Вуз норм, не шарага. Есть знакомая тян там учится, она норм язык знает, и говорит на пересдачи приходится ходить, хотя она даже понимает на слух английский.
сам я учил в школе немецкий. Ну как учил.. Не учил, но был немецкий. Знаю слов 20 в лучшем случае. И это с числами. Английский на таком же уровне.
Какой выбрать и почему? какой перспективнее?
поступаю в мед. потом хочу на психиатрию пойти (мб потом поменяется, но пока выбор такой).
если куда-то перекатываться, то не в сша. эта страна мне не интересна.
Да и в германию легче всего.
так же я нацист, и очень интересна история и творчество Германии до середины прошлого века.
Т.е. тут язык поможет.
Английский же-поможет в любой стране, как туристу. Или на первое время пребывания, если перекатываюсь. Так же на английском есть всякая литература, ролики, статьи, исследования. Фильмы в оригинальной озвучке.
Два варианта. Изучать немецкий в вузе, а второй (английский) в свободное время, очень вяленько.
Или наоборот. Английский в вузе, немецкий вяленько дома.
Не уверен насчет переката. Но если и будет-то не туда, где нужен английский (не штаты)
И вопрос. Когда выбирается язык. Сразу при подаче документов, или после зачисления? И можно ли его поменять, например, если при подаче документов выбрал, и до сентября изменить?
Вообще какой вы изучали, и есть ли тут те, кто выбрал другой, не тот, что в школе изучали?
Ну и последний вопрос, есть ли в мед вузах "начальные группы", где с 0 изучают языки? Чтоб не отчислили за неуспеваемость по иностранному
Привет, тоже хочу в аир
+ у меня хорошо получается принимать решения в острой ситуации, не ощущаю паники, только собранность
+ аналитический склад ума, настроенный на решение проблемы в т ч нестандартным методом
+ нравится большую часть работы отдыхать, а меньшую ебашить
+ хочу в настоящую медицину
+ не люблю писать ИБшки в вузе
+ люблю риск и адреналин
+- хочу быть на операциях, но быть хирургом я рот ебал
- не хочу экстренно выходить на смены во время выходного
- мало общаться с пациентами. Мне нравится с ними общаться
Вижу перспективу в аир как профессию с большим потенциалом. Не заменит ии. Можно уйти в ремку, можно уйти в анестезиологию. Например в стоматологии чилить на старости, в часке.
Зарплаты достойные.
Можно работать 1/3 и иметь кучу выходных для увлечений и хобби.
В чем я не прав?
Сколько получаешь, где работаешь?
Тебе уже ответили
Немецкий в вузе, английский в свободное время?
А есть ли "начальные группы" в меде?
Ты нихуя не выучишь язык в меде. Это просто пары которые надо отсидеть
Учи сам
ты тупой какой то
>в германию легче всего.
>так же я нацист
Может скажем ему?
>что только 10% разбавят.
Это гораздо ближе к истине. Новых вопросов примерно столько и будет. Так что если старые знаешь нормально, то сдашь. Могут новые вообще не попасться лично тебе, это рандом.
Какие подводные работать врачом терапевтом в обычном терапевтическом отделении «ЦРБ»?
Русский язык освоить для начала. На хорошем уровне грамотности и широким запасом слов.
ты очень тупой селюк, покинь тред
нахрюк не нужен дое
Смотря какой график и нагрузка.
Можно спокойно чилить с 8 9 до 14 13 30, нихуя не делая и принимая 1 бабку в час.
А можно ебашить через сутки, бегая по все больнице как в жопу ужаленный.
> можно работать а можно и не работать
Очень полезный дельный совет. Как обычно спросив совет на дваче, получаешь самую эссенцию знаний. Спасибо.
Далеко пойдем с такими товарищами.
Пости сам дельное. кто?я?
>в 2018 году в стране насчитывалась 1361 центральная районная больница
Какой ты ответ хочешь услышать, чучело? Можно работать за сорокет в алтайском крае без возможности сходить покурить и поссать, можно работать на ямале за 300к/сек и нихуя не делать. Раз на раз не приходится.
Навалил кринжа. Что наркотизатор, что реаниматолог - однохуйственно невидимая и не вспоминаемая никем хуета, кроме прокурора. Дай наркоз и завали ебало. Хирургу уже занесли. Хохлаанестезиолога спросить забыли.
Буквально специальность-помойка. Что-то на уровне биомусора типа скоряка или терапевта. Если работать в А, то это подтанцовка для хирургов из серии "сделай стол повыше, поправь стол". Это если ещё не вспоминать, что в рашке всякая хуйня типа коронарок/эгдс с седаций требует присутствия анеста, где ты просто статистом ебалом щелкаешь.
>аналитический склад ума
От слова анал? Средний аир это быдло типа фельдшера. Ой давление низкое? Надо покапать/прессоры. Ой брадикардия? Надо атропина ебнуть.
>хочу в настоящую медицину
'Это да, долгое время в маааскве лайфхак был, что будучи аиром можно было в любую больницу устроиться. Сейчас кмк ситуация чуть чуть другая.
>не люблю писать ИБшки в вузе
Реаниматологи больше терапевтов бумагу марают.
>люблю риск и адреналин
Это называется "я у мамы инфантил". Нет никакого адреналина в прыганье на бабке в ночи.
>Зарплаты достойные.
))))))))))))))))))
>Можно работать 1/3
Скорее 1/2, потому что ой кто-то в отпуске, кто-то на больничом. Но в целом да, действительно ощущение, что свободного времени больше.
А какие специальности тогда норм кроме айти лол
Да дохуя норм специальностей, просто тут как обычно - кого в спину есть кому толкать тот будет в преимуществе. Но аир это буквально ставка на говно. Мой одногрупник имеет папу дмн, большого специалиста как в А так и в Р. При этом папа его показательно в хирургию запихал. Когда в рф жил, то работал в РЭДЛе. Было просто потрясающе. 6 часовой рабочий день (из рентгена), зп где-то 2-2.5к в долларах была+спасибо от поциентов. Работа тупо дежурствами. Самое заебись было в том, что я пациентов вообще не вел. Если на дежурстве некого стентировать то можешь чем угодно заниматься - спать, дрочить, иррать в вов.
>Когда в рф жил
А сейчас где?
>Средний аир это быдло типа фельдшера
Это в быдло реанимациях, ты не видел нормальные отделения в нормальных больницах.
>Зарплаты достойные.
Странно с этим спорить. Где начальство не греет зарплатой просто не нужно туда идти.
>Можно работать за сорокет в алтайском крае без возможности сходить покурить и поссать
А что там с ними не так?
>По специальностям где можно заработать - кардиология, травматология -ортопедия, дерматовенерология
Травма хз, за счет левака если только. В частных особо нахер не нужны, 90% лечения это стационар.
Кардиология — только про наличии нескольких сертификатов, работы в нескольких местах, раскрутке.
Дерматология — тут врать не буду, почти не знаю ничего по ним.
Хелп. Если прошел порог минимальный ЕГЭ. Ну чтоб ЕГЭ "сдал". Но не прошел минимальный порог в вуз по 2ум предметам. Даже платка пролетает.
По целевому могу поступить? Или там тоже нужны минимальные баллы вуза
По целевому могу поступить? Или там тоже нужны минимальные баллы вуза
Попробуй
>Странно с этим спорить. Где начальство не греет зарплатой просто не нужно туда идти.
Ты реалии на земле не учитываешь? Никто не будет аир быдло греть. ЗП получают уважаемые люди, которые больнице бабки приносят, закрывая квоты.
>Это в быдло реанимациях, ты не видел нормальные отделения в нормальных больницах.
А это какие такие больницы? Я успел в 3 больницах в мааскве поработать, включая небезызвестную помойку на сухаревской.и везде ситуация была плюс минус одинаковая. Единственное исключение про которое я слышал это рцнх, но это мнение третьих людей.
См.
Ты просто перегорел вот и пишешь херню
Потрясающая аргументация. В целом, если на большее мозгов не хватает, а в полуклинику пиздец не хочется, то и аир сойдет. Бабки сами себя не заебашат.
Какая еще аргументация.
Ты можешь просто объяснить почему бугуртом пропитаны все твои посты?
Я не тролю. Просто пытаюсь понять почему такая тряска
> Да дохуя норм специальностей
Понятно
Иди в аир, главное слюной на наркозе не капать и всё получится.
Да давай отпустим уже аир в сторону. Вот ты какие специальности уважаешь?
Ниггер, я там выше писал уже пространный ответ на этот вопрос. Если коротко, то воп, смп, аир (и неврология) = говно. Всё остальное зависит от твоих возможностей и предпочтений. Если прямо душа страдает без наркоза иди в аир.
> пук
>больнице бабки приносят, закрывая квоты
Хирурги например? И что они будут делать в условиях нехватки АиР?
>А это какие такие больницы? Я успел в 3 больницах в мааскве поработать, включая небезызвестную помойку на сухаревской.
Когда это было? Может ещё когда пчеловод мэрствовал?
Я не защищаю тут аир, там каждой твари по паре, но лично в моей больнице они зарабатывают выше всех, включая завов отделений, при графике 1/3-1/4 стабильно, стационар скоропомощной, да, но и не 100 наркозов в день. Кто-то тянет левак еще, там потолка нет как говорится.
Выше только зп у замов главного и то у них она складывается процентов 80 за стимулирующие, премии и тому подобные пАйки, которые, которых баландер-главный может дать или не дать.
Где выше? Я лично только зашел в тред, не читал 100+ сообщений.
Ты я так понял перекатился, ну молодец, только не всем это светит, поэтому люди и спрашивают куда двигаться в условиях России и Украины чтобы не проебаться.
«И Украины» хотел спойлером сделать, проеблся
Отсюда х людины съебали давно уже
Проеб проебыч, тебя спасет только платка в СПбМСИ или Реавиз, там хоть подобие медвуза, в синергию и РГСУ не иди
>неврология
Мануальщики, рефлексотерапевты и прочие массажисты с дипломом врача и зарплатой стоматолога вошли в чат
Получать выплату в полном от ФСС, ебашить за копейки основной зарплаты
А по целевому что? Ниже проходных можно по нему поступить?
Помню от ФСИН давали целевые, там проходили околопорогщики, это был отдельный кек-лол, но ты бы подумал может медицинский это не твое если ты даже ЕГЭ сдать не смог нормально?
Спасибо. Закрываем.

ПОСЕТИТЕЛИ ТРЕДА 2024 ЭДИШОН
Наступил 2025, опрос окончен, посмотреть ответы: https://docs.google.com/forms/d/e/1FAIpQLSe-HTvcE3sHWntgPp6ICxR2V5Rt5CMAjwKntk44QhnL2fWsGQ/viewanalytics
https://docs.google.com/document/d/1U77kmTZVo90m_YPa_S21HinhQdCb7BGC7Do5QU8SmoQ — ответы на платиновые вопросы.
Тык https://pastebin.com/q7XF9jLE и тык http://pastebin.com/dqmLxdXJ — влажные пасты про некоторые мед специальности.
https://docs.google.com/spreadsheets/d/1ZzvYJhoSj1yFQ2gT7dLr0_xBc-07Z1Nt2C1TU1DXE24/edit?usp=sharing — сравнение вузов для поступления. Оставь отзыв о своем!
Законодательная база:
Приказ 700н: https://base.garant.ru/71250136/
Приказ 707н: https://base.garant.ru/71231064/
Приказ 212н: https://base.garant.ru/71692980/
ФЗ 323: http://www.consultant.ru/document/cons_doc_LAW_121895/
Приказ 210н: утратил силу
Новости в здравоохранении и мед. образовании, а также аккредитации: vk.com/credit_med
В тред призываются энтузиасты для переписывания и дополнения фака!
Предыдущий тред: